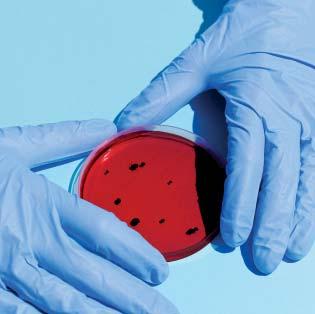

MEPC 81: Mid-term measures
Blowdown: Methane slip focus
Near-sea electrification: First world problems
Ammonia tests: Lubmarine insights
ALSO IN THIS ISSUE: ABS’ view on data | MEPC81 BWTS update | Holy Boss cap | Nuclear future

A New Milestone in Liquefied Hydrogen Transport
MARCH/APRIL 2024 Vol. 105 Issue 1220

CONTENTS MARCH/APRIL 2024

NEWS
5 6
15 First Evergreen CCS Retrofit
Evergreen’s Ever Top has become the world’s first Neopanamax to be retrofitted with a CCS system, after a SMDERI CCS system was installed at Huarun Dadong Dockyard Co., Ltd. (HRDD).
35 First G45 type with an EGR bypass
MAN ES licensee Mitsui has successfully delivered the first MAN B&W G45 type to feature an EGR bypass.
38 Mid-term
matters
Discussions about potential carbon levies as well as fuel standards will continue in September 2024, after ISGW-GHG considers the outcome of the Comprehensive Impact Assessment.


42 REGULARS
6 Leader Briefing
Updated Marine Vessel Rules include new functional requirements and a risk-based methodology to accommodate the latest technology, writes Dan Cronin, VP Class Standards & Software at ABS.
40 Design for Performance
Utilising holes in a boss cap can eliminate propeller hub vortex cavitation and reduce associated propeller efficiency losses, Dr Batuhan Aktas of EcoMarine Innovations tells The Motorship.

FEATURES
18
14 Methane slip focus on blowdown
Engine makers have ongoing work underway to reduce methane slip, including tackling emissions from blowdown, Wendy Laursen writes.
16 Emissions data CHEK
The CHEK project’s analysis of the emissions reduction potential that multiple energy saving technologies offer a Kamsarmax bulk carrier paves the way for more accurate ESG reporting.
20 Resisting siren calls
Despite technical advances, high upfront capital costs and battery energy density constraints mean alternative fuels and ICEs remain the path to decarbonising deep-sea vessels.
28 Methanol concerns move to pricing
The solutions available for methanolfuelled 4-stroke engines and retrofit packages are growing, but there are still concerns about their financial viability.
30 Lubmarine’s ammonia test results
5
5
5
5
42 Ship Description
A new generation of hybrid 5,400dwt coasters will lower CO2 emissions per cargo unit by as much as 50%, according to its Nordic owners.
Dr Olivier Denizart, Technical Manager at Lubmarine, shares some of the key findings from Lubmarine’s latest R&D projects on future fuels including an NH3-fuelled engine.

Social Media Linkedin Facebook Twitter YouTube Online motorship.com
Latest news
Comment & analysis
Industry database
Events Weekly E-News Sign up for FREE at: www.motorship.com/enews For the latest news and analysis go to www.motorship.com MARCH/APRIL 2024 | 3
will take place this year in Hamburg, Germany. Stay in touch at propulsionconference.com
The Motorship’s Propulsion and Future Fuels Conference
ThMthi’PlidFtF

VIEWPOINT
NICK EDSTROM | Editor nedstrom@motorship.com
Thank You For The Music
One of the first things that I was told when I started at The Motorship in December 2018 was battery hybridisation was unlikely to become widely adopted within the deep-sea shipping sector. The technological barriers to uptake were simply too established, ranging from the weight of the battery systems themselves all the way through to questions about charge/discharge rates and battery cell longevity.
The rapid development of electrification in the automotive sector has driven a number of advances in associated sectors, including battery cell technologies. These advances have led to steady improvements in the performance of battery cell installations, which in turn is likely to transform the cost-benefit calculus involved in integrating such systems on board vessels.
It is a mark of how fast technology has developed over the intervening period that CIMAC will be conducting a survey of its members to gauge attitudes towards the relative advantages and disadvantages of introducing large scale Energy Storage Systems onto deep-sea vessels.
We address the issue in a number of features in this month’s issue, comparing the relatively slow penetration of ESS systems in larger vessels’ propulsion packages with the faster pace of evolution in the near-sea and short-sea ferry segments.
One recurring criticism of hybridisation technologies is that they will introduce significantly greater complexity into onboard systems. However, the roll-out of autonomous and semi-autonomous navigation – we include reviews of several of such projects in this month’s issue – will transform the complexity of onboard systems. (I have postulated that this will have knock on effects on the operational lifespan of vessels, as higher upfront costs will encourage longer amortisation periods, quite apart from the improved insight into vessel wear and tear offered by digitalisation tools).
All Change
This issue will be the last issue of The Motorship that I will have the pleasure of editing. After just over five years, one pandemic and one of the most sustained periods of technological change in the industry since the Industrial Revolution, it is time for someone else to take over the reins.
This means that I will miss the growth of methanol fuelled shipping in a number of different commercial segments in 2024, as well as the upcoming addition of ammonia to the range of fuels upon which vessels are operating in both the 2-stroke and 4-stroke markets. To say nothing of the propulsion sector.
I will be leaving the maritime industry and returning to the world of market reporting, with a focus on renewable fuels. I very much hope to remain engaged with the maritime industry, not just because of its importance to all the market transitions that are occurring, but also because I have made so many friends and excellent contacts over the past few years.
From a personal perspective, it has been very rewarding to meet, get to know and report on the work of highly capable, intelligent people who are struggling to resolve challenges for the first time. The term ‘hard to abate’ doesn’t really capture the scale of the endeavour you are all engaged in. It has been a tremendous privilege.
Fjord1 to operate four autonomous ferries on domestic service

Fjord1, the Norwegian domestic ferry operator, has signed a contract with the Norwegian Road Administration to operate four autonomous, electric ferry nnewbuildings on the crossing between Lavik and Oppedal, the company said in a statement.
The four vessels, which will have a length of 120 m, will be able to carry 399 passengers and 120 cars and they will be built at the Tersan shipyard in Türkiye. All four ferries are scheduled for delivery in the first half of 2026 and the contract to operate them will take effect on 1 September.
The contract covers eight years from 2026 and it includes an option to extend it by a further three years. A total of 23 different functions will be automated from 2027, starting with docking and undocking and later on, including autonomous navigation. The crossing on which the vessels will operate is 5.6 km and it will take 20 minutes.
The ferries have been designed by Fosnavag based HAV Design, which has so far designed 18 electric ferries for Fjord1, including the now ordered ships. The autonomous ferries differ from other vessels HAV Design has produced for Fjord1 in that the systems onboard must be simpler, so that they can be easily monitored and controlled from a station ashore, said Jan Magne Goksøyr, Vice President Sales at HAV Design.
Autonomous but not unmanned “It is important too note that these vessels will be autonomous, but they will not be unmanned. The Norwegian flag has made no openings for carrying passengers
on an unmanned vessel. The captain can lean back, but he cannot leave the ship, Goksøyr told The Motorship.
Norway has been a leader in the development of electric ferries and as the country has lots of green hydro power and several domestic ferry services, there are good prospects for future orders for electric ferries in the country. As batteries get smaller and smarter, the outlook for these vessels is encouraging elsewhere as well, provided that the electricity they use has been provided from green sources, Goksøyr pointed out.
The Tersan Shipyard that will build the four Fjord1 ferries has also built the four 15,800 gross ton ferries that Havila Kystruten operates on the long coastal run between Bergen and Kirkenes along the west coast of Norway.
In December 2023, Tersan bought the Havyard Leirvik Shipyard in. Norway in a move that it said would strengthen its position in northern Europe. “We have already been collaborating with Havyard Leirvik on project base cases, although such collaboration had been only to some extent it has always worked well and showed promising signs for a potential more expanded partnership,” said Ahmet Paksu, vice chairman of the Tersan board, in a statement.
“By combining our expertise and resources with those of Havyard Leirvik Shipyard, we will be able to strengthen our position in the global shipbuilding industry,” he concluded.
NEWS REVIEW 4 | MARCH/APRIL 2024 For the latest news and analysis go to www.motorship.com
8 Fjord 1 autonomous ferries
Ever Top, a Neopanamax container vessel owned by Taiwanese liner operator Evergreen, has been awarded a SCCS-Full class notation by ClassNK, signifying that the vessel is equipped with an onboard CO2 capture and storage (CCS) system.
The vessel is the world’s first Neopanamax container vessel to be retrofitted with a CCS system. The CCS system, designed and developed by Shanghai Marine Diesel Engine Research Institute (SMDERI), were installed at Huarun Dadong Dockyard Co., Ltd. (HRDD).
ClassNK reviewed the system components and the installation plan, aligning with its comprehensive “Guidelines for Shipboard CO2 Capture and Storage Systems.” The risk
MAN Energy Solutions has announced the production of a 3.9m diameter Cluster 5 Double Layer SCR (Selective Catalytic Reduction) catalytic converter for MITSUI E&S Co., Ltd. The SCR unit - the largest the company has ever builtcomes ammonia-ready.
The 3,900 mm diameter Cluster 5 Double Layer has a total weight of 28 metric tons, and will shortly be available for series production. The quality of the product was confirmed during the final inspection by MAN Energy Solutions and MITSUI E&S. Following a successful water-pressure test, the component was subsequently shipped from Dalian, China to Tamano, Japan.
Dr. Daniel Struckmeier, Head of Sales & License Turbochargers &
NH3 AFSS launched
FIRST EVERGREEN CCS RETROFIT

assessment through Hazard Identification (HAZID) and the onsite installation process were also examined.
The retrofit installation of SMDERI’s amine-based CCS system on board the EVER TOP extends the history of
8 The MAN B&W S90ME-C engine on board Evergreen’s Ever Top container vessel was retrofitted with a SMDERI onboard CCS unit at Huarun Dadong Dockyard Co., Ltd
cooperation between SMDERI and MAN Energy Solutions in CCS applications. Ever Top is equipped with a MAN B&W 11S90ME-C9 main mover.
The Motorship previously reported that SMDERI had received a first order for an onboard CCS system in connection with an order for 12 x 82,000 dwt Kamsarmax vessels at Jiangsu New Hantong Ship Heavy Industry in April 2024. The Kamsarmax vessels have been specified with MAN B&W 6G50ME-C9.6 main movers.
Largest MAN ES SCR for Mitsui E&S

Exhaust Gas Treatment APAC, said: “As the very first SCR for an ammonia engine anywhere in the world, this is a historic moment.
As the largest, high-pressure SCR we have ever built, this marks a new milestone for our business. The new equipment also passed
Mitsui H2-fuelled Test
its Factory Acceptance Test without any major issues and I congratulate everyone involved in this groundbreaking project.”
MAN SCR (selective catalytic
Green Corridor Nears
reduction) control systems are integrated into the overall engine-control system and adapted to the fuel-injection system and turbocharger, enhancing the efficiency and reliability of the entire system. Up to 2.5 g/kWh of fuel-oil consumption can be saved thanks to the integration of MAN SCR and optimised control strategies compared to the use of an SCR system provided by a third-party supplier. Besides reducing NOx emissions by up to 90%, they also deliver IMO Tier III compliance and increased efficiency in respect to fuel and urea consumption.
BRIEFS
EGR bypass for G45
Wärtsilä Gas Solutions launched a commercial Ammonia Fuel Supply System (AFSS) for ships able to operate with ammonia fuel in late February. The groundbreaking solution is available for both liquid and gaseous fuel. The announcement follows the news that the first NH3 fuel supply systems will be installed on two new gas carriers being built at Hyundai Mipo Dockyards (HMD) in South Korea.
Ports must be able to check the background of all vessels and show bodies such as OFAC that they have the technology to screen ships for suspected sanctions evasion
Mitsui E&S completed the successful first running of a large bore 2-stroke test engine on hydrogen at its Tamano Plant in Japan. The successful combustion was performed on one of the cylinders of a modified MAN B&W two-stroke 4S50ME-T type in October 2023. The test was successful at 100% load operation, with promising data regarding an absence of hydrogen leakage from the gas supply equipment. The gas supply system was developed by Mitsui.
A new green shipping corridor is set to be established between Singapore and Australia, following the agreement of an MoU between the two nations on 5 March. Both countries have undertaken to work with interested partners to develop zero or near-zero fuel supply chains. The deal is expected to have implications for international iron ore, thermal and coking coal, and bauxite and alumina supply chains.
MAN ES licensee Mitsui has successfully delivered the first MAN B&W G45 type to feature an EGR bypass. The Makita-built 6G45ME-C9.7-EGRBP will be the first of its type worldwide to feature EGR bypass, which allows the engine to match EGR operation to engine load to deliver the required NOx emissions reduction. The first reference with Accelleron’s A255-L turbocharger will be deployed on a 40,000 DWT bulk carrier for Japanese shipyard.
NEWS REVIEW For the latest news and analysis go to www.motorship.com MARCH/APRIL 2024 | 5
‘‘
8 The Cluster 5 Double Layer has a diameter of 3,900 mm and a total weight of 28 metric tons
RISK-BASED CLASS RULES
NEEDED FOR MARINE SECTOR
Updated Marine Vessel Rules include new functional requirements and a risk-based methodology to accommodate the latest technology, writes
An increasingly complex, digitalised maritime industry is challenging designers, shipyards and vendors to deliver the kind of vessels that can safely navigate the transition to a low carbon, high efficiency operating environment. With new technologies enabling innovative approaches to design and performance across all types of vessels, the industry wants to know that class rules are keeping pace with developments.
The emergence of a goal-based approach from the International Maritime Organization (IMO) signaled a seachange in the way regulators could develop criteria that could be applied to any technical solution, rather than the traditional prescriptive approach.
The exponential growth in technology development that we expect over the next decade and beyond has enabled designers and builders to accommodate more and more advanced technology within their concepts. Class and others have been mindful of the need for a clear pathway to understanding the risks attached to new technologies, whether for assets or the humans that work with them.
In particular, the technologies of decarbonisation that are novel and innovative, demand a fresh approach that enables shipping to achieve a safer and more sustainable energy transition.
The rate of technology development is challenging to an industry which is often incorrectly labelled as slow and resistant to change. Owners and operators are looking to move quickly to cut emissions and maintain a competitive edge. This necessitates a requirement structure that applies a risk-based approach to class rules, which helps by quickly and efficiently identifying unintended safety consequences of employing new technology onboard their vessels, thereby allowing owners and operators to make fleet-wide decisions with speed and confidence.
In response to growing demands for a framework that can enable innovation, ABS has updated the Marine Vessel Rules and introduced new Rules for Alternative Arrangements, Novel Concepts and New Technologies applying functional requirements, developed in accordance with the guidance in IMO Circular 1394, and risk-based methods to designs that do not have established Rules.
This approach is aligned with the IMO process for alternative arrangements. ABS has received positive feedback from flag Administrations who also face the challenge of evaluating new ideas against regulations that were often written with a speci technical solution in mind. By following the IMO framework and leveraging predefined functional requirements, the process of obtaining both class and flag approval of alternative designs will be far more efficient.
g, to provide a process for ular 1394, and risk-based ve established Rules. he
s who also face ideas with a specific wing IMO
Dan Cronin, ABS
a lighter vessel, equipment to handle new fuels, or a new vessel type that operates in a manner not seen before.
The updated ABS Rules enable shipowners to integrate new technology knowing that they have been through a riskbased process as part of a comprehensive ABS Class review. At the C-suite level, the enhanced rules create an environment to explore the impact of incorporating advanced digitalization capabilities and new decarbonization technology into a fleet.
For shipyards and technical personnel, the Rules provide a series of pre-defined objectives and functional criteria. ABS working with other stakeholders can determine the acceptability of the new technology and identify risks to existing systems. With approval times reduced by as much as half for the adoption of new technology, project managers can make fleet-wide decisions with speed and confidence.
ABS prescriptive Rules remain in place for conventional designs, technologies and arrangements that follow the traditional approval process.
The Rule enhancements are a result of a multi-year collaboration with industry, shipyards, shipowners, equipment manufacturers, designers and regulators. Over 600 ABS clients took time to provide feedback through ABS Technical Committees, questionnaires, and other avenues.
In addition to the request for a framework adaptable to new technology, two other important requests were to provide easier access and to improve the clarity of the existing Rules.
To meet those requests, ABS has also released Rule Manager 2.0, an intuitive application that allows users to quickly search and access content across the suite of ABS Rules and Guides. This follows the 2023 launch of the industry’s only Custom Rule Book application, a powerful tool which allows users to instantly create tailored rules sets for their specific vessel or project. Rule Manager 2.0 will also be available to MyFreedom™ Portal subscribers which will allow more personalization and content.
Commentary and updated text simplify class requirements, reducing interruptions during survey and plan review by clearly describing what is required for compliance. New figures have been added to explain complex technical content more easily.

The new Rules and approach can address any innovative idea that does not have de requirements. Some examples may be the incorporation of new materials for
ing both class signs will be far an address ave fined may be for gp wh images and ha technical content more progressive vessel includ craft and h
ABS will progressively release updated Rules for popular vessel types including offshore units, barges, high speed craft and light high speed naval craft.
 8 Dan Cronin, VP Class Standards & Software at ABS
8 Dan Cronin, VP Class Standards & Software at ABS
The updated ABS Rules are built to adapt to a new and rapidly changing technological world, creating clarity around complex topics and simplifying access to the information the industry needs. By enhancing ABS Rules with risk-based requirements and strengthening the technical content to account for compatibility with objectives, functional requirements and prescriptive criteria, ABS has created a robust infrastructure to enable the innovation and technology to support our clients and the wider maritime industry’s evolving decarbonization and digital ambitions.
The c clarity aroun access to the AB and strengthe compatib a ro innovation an and the decarb

LEADER BRIEFING
6 | MARCH/APRIL 2024For the latest news and analysis go to www.motorship.com

















MID-TERM MEASURE DEBATE WILL DOMINATE RUNUP TO MEPC82
The 81st meeting of the IMO’s Marine Environment Protection Committee (MEPC) in London on 18 to 22 March 2024 was held the week after the Intersessional Working Group on the reduction of Green House Gases (ISWG-GHG 16)
Decisions about the final shape of mid-term measures to improve the economics of operating on fuels with lower greenhouse gas emission (GHG) profiles were delayed until ISWG-GHG 17, which is expected to be held the week before MEPC 82 in late September 2024
The working group meeting will take into account feedback from a two-day workshop into the findings of an IMO commissioned Comprehensive Impact Assessment, to assess the impact of potential mid-term measures on states, as well as individual trades.
While ISWG-GHG agreed to develop a goal-based marine fuel standard regulating the phased reduction of marine fuel’s GHG intensity as part of the basket of mid-term measures, there was less consensus upon whether an economic element should be introduced independently or integrated into the goal-based marine fuel standard.
Proposals for more sophisticated flexible compliance strategies also divided committee members, with some delegations raising concerns that countries without the experience of operating in complex trading markets may be disadvantaged.
The Working Group also noted the wide support for using the existing IMO instruments for reporting and verification requirements while also noting the necessity to develop additional tools, such as a central registry.
This focus on improving the consistency and reliability of DCS data quality was seen elsewhere: the MEPC requested the IMO Secretariat review the IMO DCS to assess its suitability for the implementation and enforcement of regulatory GHG measures.
MEPC 81 also adopted amendments to add granularity to fuel consumption data which must be reported by ships of 5,000 GT or above, as well as information related to attained CII. These amendments, amongst other things, give guidance on the methodology for recording fuel consumption per consumer as well as how to record when a ship is under way/ not underway for the purpose of data recording to the DCS.
Significant progress was made in the development of a life cycle GHG assessment (LCA) framework, and the MEPC adopted the 2024 Guidelines on Life Cycle GHG Intensity of Marine Fuels (2024 LCA Guidelines) (MEPC.391(81)).
As previously noted by The Motorship, this will lead to ever deeper scrutiny of emission factors related to upstream fuel production and onboard fuel consumption. (The 30 year or 100 year methane emission timeframe problem). The Committee’s decision to embed onboard carbon capture and storage technologies in the development of LCA boundaries suggests that onboard CCS will become an important technology for improving the environmental footprint of conventional fuels over the intervening period.
The ISWG-GHG expressed a wish to re-examine the reduction trajectory imposed by accepting the ambitions in MEPC.377(80) once the fuel standard enters into force, rather than accept a straight line reduction between a 20%

reduction by 2030, a 70% reduction by 2040 and net zero by 2050. The focus of discussions on technical discussions about the correct base line to use indicates the contribution of highly skilled shipping economists. They will be fully engaged in the months ahead, as the terms of reference of a Fifth IMO GHG Study will be put before MEPC 82 in October 2024.
Timelines
It is worth noting that ISWG-GHG plans to reach a recommendation on the preferred mid-term economic and technical measure at its ISWG-GHG 17 meeting in September 2024, which will be considered and potentially recommended for adoption at MEPC 82 in October 2023. The approval of the measure will subsequently occur at MEPC 84 in April 2025.
This timeframe is unexceptional, but the highly politicised nature of the topics under discussion within individual IMO member states raises the risk that political transitions after national election results, or alterations to the orientation of European Commission political appointees may well alter negotiating positions.
Leaving aside potential alterations to the political environment in the USA and the European Union, several technologies are likely to reach technical maturity within the next 12 months, including onboard carbon capture and storage for 2-stroke engines, ammonia-based combustion and potentially hydrogen-based combustion.
Despite their technical maturity, the adoption of these technologies and their necessary (negative and positive) supply chain infrastructures more broadly will rely upon the introduction of relevant economic tools.
8 Expect MEPC 82 to approve the terms of reference of a Fifth IMO GHG Study in October 2024
REGULATION 8 | MARCH/APRIL 2024 For the latest news and analysis go to www.motorship.com






Motorship Issue for Motorship HalfPg 2024 outlines indd 1 3/17/24 10:27 PM For Marine Decarbonization; The Answer is CO2 Mineralization. * Unique and innovative technology for economical CO2 capturing from ships * Customized design based on the CO2 capture rate optimized for each ship’s operating data. Please contact sales@hiairkorea.co.kr
BACK TO THE FuTube: WÄRTSILÄ CHECKS BEARING
Wärtsilä starts afresh to plan its shaft line strategy, Paul Gunton reports
Thomas Pauly has an important job: he is a General Manager at Wärtsilä’s Shaft Line Solutions (SLS) and is responsible for its future portfolio and market intelligence. In any company, those roles form the basis of its success but in the competitive world of shipping, where price is often the decision-driver behind technology choices, they are especially vital.
So since 2017 he has been asking some simple questions in 180 customer interviews that generated 3,800 separate pieces of information. Mr Pauly himself conducted 150 of them and the headline outcome of all this work was stark: in general, customers believe that today’s equipment is good enough.
He was speaking to a small group of invited guests, including The Motorship, in late March in the heart of SLS’ Bearing Centre in Vigo, Spain, where he summarised the research and drew two important conclusions from it. One identified what customers wanted from their seals and bearings while the other discovered where their pain points were.
foundation for all our innovations,” he said, going on to describe how Wärtsilä’s response had brought its international teams together to find solutions to address customers’ wishes and pain points in “a masterpiece of cross-collaboration”.

Those two lists were noticeably different. What customers most wanted from their seals and bearings, the survey showed, was ‘100% fail-safe [operation]; no leaks or oil spills’.
But their biggest pain point highlighted a desire that bearings should ‘handle slight shaft line bending’, which ranked only seventh on the list of what customers thought they wanted.
The variation between the two sets of priorities prompted Mr Pauly to remark that “some voices were quite loud but their pain was quite low.” And vice versa, the analysis showed.
This was not just an academic exercise. It has formed “the
This masterpiece has been dubbed ‘FuTube’, a name chosen to convey Wärtsilä’s view that it represents the future of sterntube technology. It consists of a portfolio of new and upgraded systems (see ‘Unwrapping the FuTube package’), backed up by a demonstration test rig – part-funded by an EU grant –located in its Bearing Centre.
Mr Pauly made no secret of the strategy behind its research and the creation of FuTube: it is to increase market share by persuading owners and managers to specify FuTubebased shafting and bearing systems in their vessels. At the moment, they leave that selection to yards, which generally use price to decide which manufacturer will supply these important components, he said.
“This is the brutal reality. The market is not desperately pushing for something new and there is an extremely low price level in the market,” he said, which is a problem not only for Wärtsilä but also for other suppliers, he said. “We decided we wanted to break out of this cycle.”
He summed up Wärtsilä’s route out of this circle in three ambitions, based on the pain points identified from its research: “the more it hurts, the more they value [a solution]” he said. FuTube is the result, he said, with the goals of reducing costs, making crews’ lives easier and avoiding damage.
Test rig demonstrates complete FuTube family
Installed within Wärtsilä Shaft Line Solutions’ Bearing Centre in Vigo, Spain, is a practical simulation of a complete shaft line, from engine to propeller. Those two components are represented by an electric motor for the engine and a device that can replicate the vertical and horizontal forces on the shaft that would arise from a propeller in various operating modes. Everything else uses standard equipment.
No photographs are available of the setup, so a brief description is useful for this report. The electric motor is connected via a hydraulic coupling to a 9.5m shaft which passes through an intermediate bearing and on to an EvoTube sterntube, fitted with
an IntelliSafe bearing. A conventional liptype seal is fitted at the inboard end and a Wärtsilä Airguard seal at the outboard end. Lubricating oil tanks and the various pumps – including the air pump for the aft seal are also included in the rig.
Jose Antonio Vazquez, SLS’ Technical Manager, Engineering, explained that the rig can be configured to represent any combination of components and propeller forces that a customer is contemplating and then be run for several days, following automated operating cycles, to demonstrate the various elements and collect data over a realistic length of time.
These cycles would particularly demonstrate the benefits of the IntelliSafe
8 Thomas Pauly asked customers some fundamental questions
bearing, he suggested. “We are producing a situation where the bearing should be wearing, but because it is protected by IntelliSafe, it will react and increase the oil film to avoid wear,” he told The Motorship. As well as these customer-focused demonstrations, during the two years it has been in use it has provided valuable insights that have helped its EvoTube and IntelliSafe development, in particular in comparing the ability of the cooled oil to reduce the bearing temperature quickly, compared with a conventional bearing. To perform that comparison on a ship would require it to be drydocked for components to be replaced, which would be almost impossible, he said.
THRUSTERS & PROPULSORS 10 | MARCH/APRIL 2024 For the latest news and analysis go to www.motorship.com
UNWRAPPING THE FuTube PACKAGE
Wärtsilä’s FuTube is a modular system, but each component is available separately, SLS Sales director Panu Sorvisto explained to The Motorship. “That's the beauty of it; it allows for flexibility"

Among the innovations he highlighted is an enhanced version of the company’s long-established Airguard seal, which it claims now offers a 10-year service interval. This saves operational costs, said SLS General Manager Thomas Pauly, not only because the seal does not need servicing at every five-year drydock, but checks can be carried out using a cherry-picker rather than scaffolding. This benefit alone will save 1.5 days from a typical 10-day drydock visit, he said.
This life extension has been achieved by using a new sealing material that is effectively a combination of the two products previously used; one for sealing against water and one for oil. It was developed as a result of experiments in 2020-21 specifically to find a way extend seal life and reduce repair and maintenance costs, rather than the shipyarddriven focus on the capital costs.
Forward of this seal is an EvoTube, which was launched in December 2023 and described in The Motorship that month. Its name reflects the notion that it marks an evolution from normal sterntubes, thanks to its shorter length, which contains the shaft line’s aft bearing.
‘‘
Ship crews are under a lot of pressure during a voyage and cannot be expected to be experts about shaft bearings
This is a simpler system than with a conventional longer sterntube, SLS Technical Manager, Engineering, Jose Antonio Vazquez, said. In addition, the EvoTube is about 8m shorter than a conventional sterntube, which provides an opportunity to have a shorter engineroom and create more cargo space, he noted.
Inside the EvoTube is an IntelliSafe bearing, which has been designed to address a startling statistic: in conventional sterntube arrangements 90% of shaft line breakdowns are caused by friction wear in the aft bearing. SLS sees the practical reality of this, since its workshop repairs about 200 aft bearings every year, each of which represents a ship being taken by tug to drydock for the bearing to be removed
and, quite possibly, an oil spill from the sterntube. “This is very expensive for owners and operators,” Mr Vazquez said.
Ship crews are under a lot of pressure during a voyage and cannot be expected to be experts about shaft bearings, he said, so “they should not have to care about is going on in the sterntube,” with the bearing system adapt to operational demands, he believes. This ambition led to the design ideas that lie behind the IntelliSafe bearing (see box).
Finally, a continuous shaft monitoring system monitors the entire shaft system. It is based on portable equipment that Wärtsilä has used for more than 20 years as a troubleshooting aid, but now it has been incorporated into a permanent control unit as part of the FuTube concept.
Jens Hyrup, Manager of Alignment Services at SLS, said that data from all the various sensors is stored simultaneously, so that if an event occurs, its impact would be seen in each sensor at the same time. Both raw and processed date will be retained, in separate databases. It is a complex system that generates a huge amount of data, he said, which can be exported and sent ashore for further analysis in case, for example, a class society asked to see it.
It uses proximity sensors to monitor the shafting – Mr

THRUSTERS & PROPULSORS For the latest news and analysis go to www.motorship.com MARCH/APRIL 2024 | 11
8 Sensors along the shaft line provide continuous information to the monitoring system
8 Wärtsilä’s Airguard seal now comes with a 10year service interval

Hyrup prefers these over accelerometers since those devices would be affected by background noise – and one of the critical parameters measured is bearing wear-down, which enables a prediction of a bearing’s lifetime; something that is especially relevant in water-lubricated systems.
Sensors are positioned in pairs – one making vertical measurements and the other horizontal – including one pair as close as possible to the propeller. That is straightforward to arrange in a newbuilding but not as easy in a retrofit installation, he said. Other locations include the forward seal
and regions of the shaft that have the highest mass, since that is where the highest amplitudes would be seen, for example in the event of propeller damage.
Although the IntelliSafe bearing also relies on sensors, there is no direct connection between that and the shaft monitoring system, but the shaft monitoring system will notice any performance changes as a result of the IntelliSafe’s lubrication processes. There might also be cybersecurity implications if the two systems were connected, he said, “so we tried to keep them apart.”
IntelliSafe is caring for bearings
Wärtsilä SLS’s IntelliSafe bearing uses sensors to provide immediate information to control oil flow in the event that there is a risk of metal-to-metal contact, which would result in expensive damage to the bearing and the shaft. SLS Technical Manager, Engineering, Jose Antonio Vazquez described a four-step development process that enables the bearing to react in real time to prevent such situations developing.
Step 1 was to include sensors within the bearing at critical places to provide information about the oil film thickness. These are typically mounted either side at the aft part the IntelliSafe bearing and provide proximity data to indicate the clearance between the shaft and bearing.
In Step 2, lubrication was improved for standard operating conditions. For example, the oil injection port is supplied with cooled oil and they are positioned so that they can provide fresh oil to the areas of the
bearing that most need it. This is achieved by arranging lubrication wash ways within the bearing to guide the oil to where it is needed, supplemented by pressure release holes to relieve any increased oil pressure.
For Step 3, however, the bearing has a specific high pressure oil injection port directly below the shaft to supply additional fresh oil directly below the shaft in critical conditions to prevent metal-to-metal contact. This is optimised to operate at all load and speed conditions.
A final Step 4 in the design added a hydraulic unit connected to a control box. This monitors all the sensor outputs to determine the appropriate lubrication requirements, reacting in seconds to deliver sufficient lubrication to prevent bearing damage.
8 IntelliSafe bearings provide lubrication when and where needed to avoid metal-to-metal contact
8 An EvoTube’s short length can allow more cargo capacity

THRUSTERS & PROPULSORS 12 | MARCH/APRIL 2024 For the latest news and analysis go to www.motorship.com
NEW METHODS FOR NEW MARKETS
If customers for its products are content with currently-available equipment (see ‘Back to the FuTube’), Wärtsilä has to reach two groups of customers that its innovations offer operational, as well as technical, benefits
Those groups are shipowners and shipyards: the former need to be convinced that they should specify Wärtsilä’s seals, bearings and supporting equipment, while yards must be willing to fit them in preference to whatever they might have included in their standard design specs or what they might have chosen based simply on price.
Thomas Pauly, responsible for its future portfolio and market intelligence at Wärtsilä’s Shaft Line Solutions (SLS), has played his part and identified not only what shipowners and manager think they want, but also what they actually need (see ‘Back to the FuTube’). Now, Wärtsilä needs to engage those same owners and managers and convince them that their preferences and pain points can both be satisfied by naming its equipment in their own newbuilding specifications.
This marks “a step change for the industry,” believes Matthew Bignell, International Business Development and Product Management specialist at SLS. Speaking to The Motorship, he described it as a positive approach, especially as FuTube’s modular nature means that shipowners can adopt just one element, or the full package of technologies. They are also relevant to both newbuilding and retrofit decisions, adding diversity into discussions.
He also acknowledged the value of the test rig in SLS’ bearing centre, since it allows a customer to see how their proposed set-up will behave in a typical vessel.
Even when an owner has decided to specify a particular system, that may not be the end of the story. Jens Hyrup, Manager of Alignment Services at SLS, recalled newbuilding installations in which the yard fitted a component and its sensors, but the corresponding control and monitoring cabinets were fitted by Wärtsilä after delivery. “It's not

something that the shipyard wants to include, because it's just more work for them,” he said.
SLS Sales director Panu Sorvisto agreed about the need to get yards onside. “Sometimes there is a reluctance to change … so we want to be their friend,” he said. This friendliness includes helping the yard to understand the impact of accepting a different technology from their usual spec, such as extra piping and cabling.
But, like Mr Bignell, he sees the owner as the driving force. When an owner asks for a particular design change, most yards are willing to modify their plans, he said, for a cost. “But we really have to be available to help. Then there is a lower resistance to implement it into the ship design,” he said.
Sterntube failures on the rise
Increasing numbers of vessels are suffering failures in their stern tube bearings, according to SLS Technical Manager, Engineering, Jose Antonio Vazquez and 90% of them are in the aft bearing. And he believes he knows why. “Increased pressure over operators and crews to meet targets makes them take risks,” he said.
His colleague Beatriz Garcia manages SLS’ Bearing Centre in Vigo, Spain, where many damaged bearings end up for repair. Speaking to The Motorship, she suggested that excessive speed, causing high temperatures in the bearings, is behind some of the damage that comes into the Bearing Centre, but she also reported another trend: some bearings are being sent
for repair that, in the past, might have simply been replaced, perhaps because the laser technology can complete repairs without the risk of deformation from pre-heating.
Among the tools in her centre is a patented laser system that can apply white metal to new or damaged bearing surfaces in a precisely-controlled sequence. It can work on bearings up to 4m external diameter and 2.5m long, weighing up to 10 tonnes and reliably achieves a bond strength between the new bearing surface and the bearing’s steel base of 100MPa. This has enabled the plant to win contracts for bearings to be used in nuclear power stations, for which a bond strength of at least 90MPa is demanded.
Mr Vazquez identified some operational
8 It is important to be friendly towards shipyards, says Panu Sorvisto
factors that can lead to the metal-to-metal contact that results in bearing damage. Among them is ‘hammering’, which can happen if the propeller is not fully submerged, which can happen if the ship is not fully-loaded and “the operators and crew are under pressure to deliver,” he said. This hammering can destroy the bond that secures the bearing material resulting in cracks that will force the ship into dock for repairs, incurring large costs and losses.
Shaft alignment is also critical – particularly at high speeds – otherwise bearing damage can occur and even the shaft might be damaged beyond repair because it could overheat and crack, putting the ship out of action for months, he suggested.
THRUSTERS & PROPULSORS For the latest news and analysis go to www.motorship.com MARCH/APRIL 2024 | 13
BLOWDOWN A NEW TARGET FOR METHANE SLIP REDUCTIONS
While engine makers make progress on methane slip from combustion chambers, MAN Energy Solutions is additionally targeting the blowdown of recirculated fuel when gas operation is stopped. Fuel supply system blowdown is the venting of pressurised methane from the engine and piping downstream of the gas valve train directly to the atmosphere. It is a routine procedure conducted before gas purging with nitrogen.
In a white paper titled Managing methane slip on ME-GI installations published earlier this year, the company stated it is reintroducing its already developed system which was introduced with its first design iteration of the ME-GI engine technology but which at the time never saw adequate market interest. As more focus has now come on emissions reductions, vessel owners and operators have started focusing on downstream emissions as well, posting the required demand for MAN ES to re-introduce their system in an updated version.
The gas return system has reported the capability to capture up to 95% of the gas emitted during blowdown. The gas can then be stored in a buffer tank and supplied to downstream consumers such as boilers or auxiliary engines rather than being emitted from the vent mast. The system will be offered as an optional feature for new ME-GI engines.
Currently, MAN guarantees a methane slip in the range of 0.2-0.28 g/kWh for its ME-GI engines across loads of 25-100%. Research quantifying emissions continues with the white paper providing results from two different engine sizes: 10G95ME-C10.5-GI (single engine on a container ship) and the smaller 5G70ME-C10.5-GI (twin engines on an LNG carrier).
Engine makers have ongoing work underway to reduce methane slip, including tackling emissions from blowdown Copyright:
Data was obtained from CEAS engine data reports and real engine operating profiles. Of the total exhaust emission profile, both engines displayed a methane content of 6-7%, calculated by Global Warming Potential. Looking at the overall vessel emissions, including both exhaust emissions and what is ventilated from the supply system, the dual engines LNG carrier, displayed a methane content of approximately 17%. For the container vessel, it was 11%.
MAN notes that the ME-GI provides owners with specific fuel oil consumption 7% less than that of a low-pressure twostroke engine and 32% less than a four-stroke genset.
ME-GI engine exhaust methane slip is only 16% of that from a low-pressure two-stroke engine (ME-GA) and only 6% of that of a four-stroke. Even with these merits research continues to reduce total methane slip. As engine exhaust values are already negligible, MAN has, with the latest technological offer, turned its sight towards the supply systems and vessel integration for further reductions. For the ME-GA engine, high-pressure exhaust gas recirculation is the technology of choice, and oxidation catalysts such as IMOKAT II are the choice for fourstrokes, along with optimized design features such as cylinder skip firing and reduction in crevice volumes.
Low-emission engines
Meanwhile, Wärtsilä recently introduced a new ultra-low emissions version of its Wärtsilä 31DF engine which can

further reduce methane emissions on a 50% load point by up to 56%. On a weighted average, this new technology can reduce methane emissions by 41% more than the standard Wärtsilä 31DF engine.
The new version, which is applied on one of the four engines on board Wasaline’s Aurora Botnia ferry, has already helped the Finnish-Swedish ferry operator further reduce the Aurora Botnia’s methane emissions by 10%. As part of the EU co-funded Green Ray and SeaTech projects, Wärtsilä piloted the ultra-low emissions concept onboard the Aurora Botnia with results verified through an independent study conducted in December 2022 by VTT, the Technical Research Centre of Finland.
Researchers from VTT studied methane slip from two of the Wärtsilä 31DF engines onboard – one in standard configuration and the other piloting the new combustion concept. These medium-speed 4-stroke engines have 8 cylinders, with a power of 550 kW per cylinder. Both engines were studied under five engine load conditions while the vessel operated on its normal route between Vaasa, Finland and Umeå, Sweden.
The study showed that overall methane emissions were lower than what has been reported by previous onboard
8 MAN Energy Solutions noted that it is developing a gas return system, which would enables reuse of almost the entire blowdown fuel amount, as an optional feature for ME-GI engines
TWO-STROKE ENGINES 14 | MARCH/APRIL 2024 For the latest news and analysis go to www.motorship.com
MAN ES
Wärtsilä launched the new ultra-low emissions version of the Wärtsilä 31DF engine to the commercial market last year ‘‘
studies with similar-sized low-pressure dual-fuel engines. Both engines emitted less methane at higher engine loads, especially compared to the lowest engine load of 10%. At engine loads of 50–90%, the new combustion engine produced 50–65% less methane compared to the standard engine, and at the lower loads (with higher absolute methane levels), the difference between the engines was even higher. At 10% load, the engine with the new combustion concept produced methane emission below 4 g/kWh compared to the over 12 g/kWh of the standard engine. At higher engine loads, the emissions from the new combustion concept were below 2 g/kWh.

Results also indicated that the upgraded engine technology had great potential to reduce overall emissions (including both CO2 and methane). Following the positive results, Wärtsilä launched the new ultra-low emissions version of the Wärtsilä 31DF engine to the commercial market last year.
The new engine technologies being developed will help shipowners futureproof their vessels against potentially tightening global requirements. From 2025, the FuelEU Maritime regulation will require ships calling EU ports to gradually reduce their well-to-wake greenhouse gas (GHG)


Wärtsilä’s new ultra-low emissions version of its Wärtsilä 31DF (the 10V31DF variant is pictured) has delivered methane emission reductions on a 50% load point of up to 56%.
version of its Wärtsilä (the 10V31DF variant is has of up 56%


intensity, including methane slip. The IMO is expected to introduce a goal-based marine fuel standard regulating the phased reduction of the marine fuel GHG intensity, also including methane slip, from 2027.
















TWO-STROKE ENGINES For the latest news and analysis go to www.motorship.com MARCH/APRIL 2024 | 15 es. ds, At ne rd ne er. pt to ne ere ne ns ve ns ket elp ll ititildithliThIMOitdt
becker-marine-systems.com Becker Twist Rudder with bulb Your advantages: • High propulsion efficiency • Strong reliability • 24/7 support
BULKER LCA QUANTIFIES ENERGY SAVING TECHNOLOGIES
The CHEK project’s analysis of the emissions reduction potential that multiple energy saving technologies would have on a Kamsarmax bulk carrier paves the way for decarbonisation solutions and more accurate ESG reporting

Researchers from World Maritime University and Deltamarin have conducted a design-stage life cycle assessment (LCA) comparing a standard EEDI phase 2 compliant Kamsarmax bulk carrier (as baseline vessel) with an optimised design that includes multiple energy-saving technologies and operation on liquified biogas (LBG) and hydrotreated vegetable oil (HVO).
The study is part of the on-going CHEK project and builds on the digital twin and lifecycle modelling that has been developed throughout the project. The results showed that the future vessel could reduce energy consumption by 31.23% compared to the baseline vessel model. A significant reduction in CO2 (48.6%), NOx (88.6%), SOx (100.0%), and black carbon (94.0%) in the tank-to-wake phase was also achieved as a result of the energy-saving technologies working in synergy with the alternative fuels.
The optimised bulk carrier model used in the LCA includes WindWings technology, air lubrication system, ultrasound antifouling system, waste heat recovery, shore power and a battery utilised for spinning reserve. A hybrid 4-stroke power plant minimises the impact of fluctuating engine loads resulting from, for example, the wind-assist technology.
The study acknowledges that there is no “silver bullet” solution for decarbonisation, so multiple technologies will have to be employed synergistically, along with alternative fuels, and this will require careful evaluation using a systematic tool to ensure optimal combinations are adopted.
The LCA methodology provides an accurate and systematic tool for evaluating the environmental impacts of the new design throughout its entire lifecycle, says Mia Elg, R&D Manager at Deltamarin. The LCA framework used consists in goal and scope definition, life cycle inventory (LCI), life cycle impact assessment (LCIA), and results interpretation, and Elg says Deltamarin now has the tools and databases to provide the analysis to ships operational today or to new ship designs on a design platform capable of evaluating how multiple energy saving devices can be combined to maximise efficiency.
The CHEK project study investigated the comparative LCA of the two vessels, future vessel versus baseline vessel based on digital models and published research, thus including raw material extraction to production, operations,
maintenance and vessel disposal. It aimed to be as holistic as possible. For example, the construction phase included also transportation of material from steel mills to the shipyard and electricity consumption in the shipyard. The future vessel had higher emissions during construction and maintenance than the baseline vessel.
Elg notes that some yards in China are already providing data on their emissions, so she anticipates vessel-specific LCA accuracy will increase further yet.
The analysis incorporated realistic modelling of the ship propulsion power system including the impact of weather on typical routes. Fuel consumption estimates were obtained from a system-level energy model “DeltaKey”, where the propulsion profile is combined with the ship’s other energy consumers.
The CHEK project is targeting long-distance shipping with its evaluation of multiple decarbonisation solutions combined on a single vessel. The project, while aiming to inform both newbuild and retrofit, has specifically involved the design of a wind energy optimised bulk carrier and a hydrogen powered cruise ship.
The three-year project started in June 2021 with project partners include BAR Technologies, Cargill, Deltamarin, Lloyd’s Register, MSC, Silverstream and Wärtsilä, among others.
“This LCA study is an important new dimension to vessel design which underscores the vital importance of adopting a holistic approach to maritime sustainability that encompasses innovative technologies, alternative fuels, and a comprehensive understanding of the entire life cycle of vessels,” says Elg. “By integrating the design stage simulations of ship fuel and energy utilisation into LCA, we are able to provide environmental assessment of the emissions of the vessel from a life cycle perspective, which is more accurate than indicators such as EEDI and CII. That way our customers can know how the design will actually impact the environment.”
She anticipates the modelling to extend beyond air emissions to water emissions (water footprint), acidification, land use, biodiversity impact and others. The next articles to be published from the CHEK project, due later this year, will be an LCA of a cruise ship running on hydrogen and the digital twin stage energy modelling results.
8 The results of the CHEK project involved comparisons of the investigated the comparative LCA of two vessels, the MSC Grandiosa and Pyxis Ocean.
TWO-STROKE ENGINES 16 | MARCH/APRIL 2024 For the latest news and analysis go to www.motorship.com
VCR NARROWS GAP BETWEEN DUAL-FUEL TWO-STROKE DESIGNS
Early orders indicate that WinGD’s latest advance to its X-DF platform could answer some of the challenges associated with low-pressure dual-fuel engines
In the comparison between low-pressure and highpressure dual-fuel engines, two things stand in favour of high-pressure, Diesel-cycle concepts: better performance in diesel mode and lower methane slip when using LNG. A new technology from engine designer WinGD aims to both close that gap and improve the case further for lowpressure engines amongst those already convinced – and there are early signs that some operators are seeing the value in variable compression ratio (VCR) technology.
As reported previously, VCR is the result of a decade-long development project between WinGD and Mitsui E&S DU Co, formerly Diesel United. It enables an engine’s compression ratio to be adapted for the first time on marine engines, optimising combustion depending on fuel type, ambient conditions, engine load and other parameters. In early tests, WinGD was encouraged by efficiency improvements in Diesel mode, but in subsequent tests, improvements in both gas efficiency and methane slip abatement have been noted.
ypg
3.1%, outsized cing the uel use.
In the most recent tests, using VCR reduced fuel consumption and CO2 emissions by 7.7% when running on diesel. In LNG mode, overall GHG emissions (including CO2 and methane) were reduced by 4.6% compared to a gas consumption reduction of 3.1%, highlighting the outsized impact VCR has in reducing methane slip, beyond the emissions saved by lower fuel use.
WinGD recently reported that it has received around 40 orders for Variable Compression Ratio (VCR) technology since it was introduced in June last year. Among the orders are engines for nearly 20 LNG carriers – the biggest vessel segment for low-pressure dual-fuel engines – but also pure car and truck carriers and bulk carriers. Given the promising test results, interest could extend into the container segment as well.
According to WinGD GM Application & Technical Sales Marcel Ott those orders indicate demand from shipowners that will only rise “as methane slip is costed into ship operation through carbon pricing, and while fuel supply flexibility necessitates peak efficiency on both LNG and diesel fuels”. With several LNG carrier newbuilds expected to be con in the coming months, Ott is optimistic there will be further orders for VCR to announce shortly.
There are further factors in VCR’s favour that may make it a popular addition to X-DF. Efficiency benefits while using LNG are highest at part-load operation, WinGD claims, making it well-suited to modern operating profiles such as slow steaming, providing the largest bene loads used most often. And it retains both the capex and opex competitiveness of lowpressure engines: the hydraulic solution has no
d that it has received around 40 ession Ratio (VCR) technology June last rly 20 LNG carriers – the or ar and truck carriers and mising iner Technical that will rise sted into n and y necessitates G and diesel G confirmed Ott is er orders y rs in VCR’s opular ile eration, WinGD ted to modern slow efits at engine both titiveness of lowulic solution has no



impact on engine footprint or installation requirements and does not need additional maintenance between
impact on engine o need additio overhauls
WinGD claims that its wide consumptio benefi
WinGD claims that its own evaluation of systemwide energy consumption and emissions show the ts of deploying X-DF engines with VCR technology. On a 174,000 cbm LNG carrier with a typical operating profile, a configuration including two 5X72DF-2.2 engines with VCR outperformed not only conventional low-pressure engine systems but also high-pressure engine arrangements in terms of LNG consumption, air pollution, greenhouse gas emissions, electrical power demand for auxiliary machinery and
On a 174,00 outperfor terms of LNG demand fuel costs.
But Ott believ improving the bus LN
8 WinGD has received around 40 orders for Variable Compression Ratio (VCR) technology since it was introduced in June last year

But Ott believes VCR can go further than improving the business case for low-pressure engines in the LNG carrier segment. He says: “We’ve seen on the testbed that VCR brings ciency in line with our own highpressure single-fuel diesel X-engines. Diesel ciency is important for operators that exibility to choose between fuels, rather than using the cargo they are carrying, and we believe that VCR could tip the business case even in segments that might traditionally have opted for highpressure dual-fuel engines.”
“We’ve seen on t diesel effi pressure single-f effi is im want full flexibil rather than u and w the business c tradition dual-fue
TWO-STROKE ENGINES
18 | MARCH/APRIL 2024For the latest news and analysis go to www.motorship.com
WinGD
Copyright:



smm-hamburg.com the leading international maritime trade fair driving the maritime transition 3 – 6 sept 2024 hamburg facebook.com/SMMfair youtube.com/SMMfair linkedin.com/company/smmfair smm-hamburg.com/news see what makes SMM the #1 smm-hamburg.com/trailer
ELECTRIFICATION SPREADING INTO THE DEEP-SEA SEGMENT
Full electrification of deepsea vessels may be some time off yet, but the outlook isn’t as grim as some might suggest

Marine technology research consultancy Thetius launched its Maritime Alternative Fuels Barometer in January concluding that while batteries and shore power can support decarbonisation, deepsea shipping electrification remains unrealistic.
The Barometer measured the gaps between the shipping industry’s perception of alternative marine fuels and the reality in terms of availability, supply, technological readiness and impact on emissions. Commissioned by SEA-LNG, it was based on an analysis of market announcements, data on alternative fuels from DNV’s Alternative Fuels Insight platform, and 25 interviews with a range of maritime stakeholders.
A majority of stakeholders perceived batteries as a shortterm option and only applicable for shortsea shipping. One interviewee stated: “The technology won’t advance enough for deepsea shipping. Even electric vehicles aren’t reliable.”
Despite this, full electrification is gaining interest. CIMAC, in cooperation with the Maritime Battery Forum (MBF), is running a survey on battery use in deepsea shipping. The goal of the survey is to find out why, for what type of vessels and for what type of applications shipowners are considering batteries and if they think that full electrification is going to be an option for them in the future.
Early starters
Electric ambitions are progressing, with ferries leading the way. The battery capacity for each of Norled’s three new ferries will be approximately 8MWh, making them the ferries
with the largest battery capacity in Norway. Meanwhile, Incat Tasmania has designed the largest lightweight battery electric ship (130m in length) so far constructed in the world for delivery to its South American customer, Buquebus. The 100% battery electric ropax will have over 40MWh of battery storage, four times larger than any battery installation that has been installed anywhere in the world for the marine transport environment, says Incat.
Two electric container ships are being built by CHI (Yangzhou) for COSCO Shipping Development. The world's first 700 TEU electric container ships will have a battery capacity of over 50MWh and will sail the Yangtze River from Jiangsu to Shanghai. It is expected that each ship will reduce CO2 emissions by the equivalent to 2,035 family cars a year or 160,000 trees.
Knowledge sharing
Shaun White, the Managing Director of Foreship (UK), has been a strong supporter of maritime battery systems for a long time. He emphasises the important role advancing safety measures and establishing standards can play in addressing misconceptions that have hindered the recognised benefits of installing shipboard energy storage solutions.
“The maritime battery is often misunderstood, with many believing that a sizable battery is necessary for environmental and operational advantages, leading to cost, space, and safety concerns. Consequently, proposals for projects face difficulties in obtaining necessary approvals and moving forward with implementation.”
ELECTRIFICATION & AUTONOMY 20 | MARCH/APRIL 2024 For the latest news and analysis go to www.motorship.com
8 Bibby Marine eSOV
Credit: Yangzhou
The maritime battery retrofit market is caught in an ongoing cycle where prices do not decrease because of limited adoption, and limited adoption persists due to high prices. Foreship collaborates with owners on battery projects, conducting everything from feasibility studies, and detailed design to installation supervision. Doing so has involved working ahead of regulations to make battery systems safer, more dependable, and better designed, says White.
Constant technological development makes it critical that the maritime industry adopts safe and uniform standards, based on well-understood, industry-driven guidelines,” says White. “Safety and standardisation will be key for confidence in and the wider uptake of shipboard battery technology.”
In its first EMSA Guidance on the Safety of Battery Energy Storage Systems (BESS) on board ships, published last year, Europe’s maritime safety organisation notes: “There is no regulatory instrument at international level on the safety aspects of using batteries in ships. This important scope has been left to and evolved through the requirements of class, industry standards and codes with limited requirements and experience from…flag states.”
The strongest trend at the moment is the uptake of lithium iron phosphate (LFP) batteries in the stationary energy storage system market ‘‘
Foreship was among the stakeholders consulted on the functional requirements for risk mitigation included in the new EMSA Guidance. The resulting document goes beyond batteries and their integration, to include the design, installation, and operation of systems, says White. “This Guidance offers a significant step forward for assurance of the monitoring, management and protection of battery safety which will encourage a wider pool of owners to consider the advantages inherent in battery systems.” Recommendations cover training and operational procedures, ventilation, fire safety, systems testing and maintenance, and relevant shipboard spaces.
Foreship has also contributed to emerging maritime guidance and industry best practices for batteries, and to developing recommended standards so that battery systems are harmonised. It was one of the 21-strong group of expert organisations consulted to develop the MBF’s first Firefighting Guideline for Maritime Battery Systems Version, published in October 2023, detailing techniques, and strategies to deal with battery systems fires on board hybrid and electric ships. The company has also contributed to MBF’s Guideline to Standardisation of Containerized Maritime Battery Systems, whose publication is expected to accelerate the adoption of both fixed and swappable shipboard battery.
An optimally sized battery can have widespread positive impacts - on engine efficiency, emissions reduction and safety, in its use for peak shaving, load ramping or as spinning reserve. Batteries are a proven technology which contributes to achieving reduced emissions during ship operations while enhancing the efficiency of many alternative ship fuels and sources of power it works with, White points out.
Technology developments
Tomas Tengner, Global Product Manager, Energy Storage, ABB Marine & Ports, is working on projects where relatively small batteries are used to hybridise shaft generator systems

on deepsea cargo vessels. “We notice a trend of increased battery capacity that may enable zero emission port calls and cold ironing in ports without shore connection. We are continuously developing our onboard power and control systems to enable efficient and safe integration and usage of ever-increasing battery sizes.”
Increased cost for emissions in combination with more and more stringent regulations is driving an increased demand for low and zero-emission solutions, and batteries will be deployed wherever possible, he says, as they offer the highest system level energy efficiency.
Battery technology is developing rapidly. “The strongest trend at the moment is the uptake of lithium iron phosphate (LFP) batteries in the stationary energy storage system market,” says Tengner. “Big investments into this technology, primarily in China, have brought the cost down significantly, and LFP cells are currently offered for below 60 USD/kWh. This trend starts to merge into the marine energy storage system space, with several marine vendors launching products based on standard grid-type LFP cells.
“Looking a bit into the future, Na-ion batteries are being developed with close to the same energy density as LFP. These batteries utilise globally abundant raw materials and have the potential to further drive the cost down, enabling even larger vessels to go fully electric.
“For vessels that are weight sensitive, such as fast ferries, the solid-state batteries that are being developed around the globe by companies such as Toyota, Prologium, Solid Power and CATL to name a few, could enable full electrification of longer routes. However, this technology is
cation of longer routes However, this is still some years away, and it remains to be seen when and how it will be deployed for marine applications.”
8 After conducting an in-depth study on the potential for a fully-electric large jack-up WTIV, GustoMSC concluded implementation remains impractical until battery suppliers improve the power density of battery cells

ELECTRIFICATION & AUTONOMY For the latest news and analysis go to www.motorship.com MARCH/APRIL 2024 | 21
8 Shaun White, the Managing Director of Foreship (UK)
For deepsea vessels, high capital cost and low battery energy density is still preventive for full electrification. “Instead, biofuels and e-fuels will be used. Higher fuel costs will put more focus on energy efficiency, which can be realized by electric propulsion such as ABB’s Azipod propulsion units®, and hybrid power plants,” says Tengner.
“With energy consumption getting more expensive –either in the form of high CAPEX for batteries, or in the form of more expensive bio- or e-fuels, propulsion efficiency becomes increasingly important. ABB’s Azipod® propulsion systems and even more so our innovative ABB Dynafin™ concept that was launched last year, can significantly reduce propulsion power requirements and save valuable MWh. When considering electrification of a new vessel, the addition of energy storage to a propulsion system can often make the difference between a dead or flying business case.”
Offshore potential
Bibby Marine recently appointed Longitude Engineering for the design of a zero-emission electric service operation vessel (eSOV). The eSOV is based on Longitude Engineering’s OSD-IMT9605 design which Longitude Engineering is now developing to Approval in Principle stage. Longitude Engineering will apply a multi-disciplined engineering and marine consultancy team to work on this project, including Bibby Marine, Port of Aberdeen, ORE Catapult, Kongsberg, DNV, Shell and Liverpool John Moores University.
The vessel will be powered by a hybrid 20MWh battery system and dual-fuel methanol generators for back-up and offshore charging capability. The vessel will provide ultra-low emission support for offshore construction, operations and maintenance activities in the offshore renewables sector in the UK and elsewhere in Europe.
Damen Shipyards Group has also designed a fully electric SOV with offshore charging capabilities. The SOV 7017 E features a 15MWh LFP battery, sufficient to power the vessel during a full day of operations. Damen’s business case analysis indicates a healthy return on investment, ranging between five and 15 years, depending on the scenario.
Damen has partnered with UK-based MJR Power & Automation, a company that has developed a 4MW charger connector, sufficient for a 70-metre vessel. The company is also working on a scaled up 8MW version that will enable charging of vessels up to 90 metres in length. Charging is carried out while the vessel is in a low power DP mode, which requires less energy than the hotel load. A full charge typically requires energy produced in just a few hours by a single turbine.
For GustoMSC’s offshore construction vessel designs, offshore charging is less practical as they are installing turbines, but fast charging in port is a potential option. “Our vessels are designed to be working 24/7. Therefore, minimising any non-productive time is crucial,” says David Inman, Sales Manager at NOV-subsidiary GustoMSC.
Inman sees full electrification as an evolution. “You start with the easier ones to do. So, in our world, that means the small crew transfer vessels that come into port every three or four hours and have lower energy usage than the construction vessels.”
However, even for the larger vessels such as wind turbine installation vessels (WTIVs), return to port can potentially occur often enough to make battery charging as part of full electric power systems feasible in the foreseeable future. Even batteries installed as part of a hybrid diesel-electric system make a lot of sense, says Erwin van den Berg, Consultant / Expert Naval Architect at GustoMSC, due to the variation in load demand during the operations undertaken

by these vessels, such as dynamic positioning, jacking and crane operations. In these scenarios, batteries can provide peak shaving or spinning reserve, reliable redundancy and an attractive alternative to a genset in a diesel-electric setup.
Unlike deepsea cargo vessels, these offshore vessels are fewer in number, are more diverse and have a variety of offshore activities, making it harder to establish energy efficiency and carbon intensity index regulations that might push development faster. Battery adoption may come in association with fuel cell uptake. Fuel cells have relatively slow ramp up and ramp down performance, says van den Berg, making energy storage a necessity.
In limiting the impact on the environment of the vessels, a holistic view on vessel design is of key importance, and to do so, the company has set up the GustoMSC Energy Efficiency and emissions Quest (GEEQ) program. “The selection of fuel type, power supply systems including electrical energy recovery and storage should match the mission equipment and the type and arrangement of the vessel. And the vessel design should be matched with the demands of the foreseen operational profile and operation areas,” says van den Berg.
As part of GEEQ, GustoMSC has conducted an in-depth study on the potential for a fully-electric large jack-up WTIV but found that, with the battery systems currently on the market, the impact on the maximum elevated weight and on the deck area is such that carrying capacity and range is too much impaired for practical implementation. “We do, however, see that battery storage capacity per unit weight is expected to increase fast in the coming years. A few years from now, a battery powered WTIV might become feasible,”
ns, ng Our re, vid art he or on ne ally full re. tric rg, he ken says van den Berg.

ELECTRIFICATION & AUTONOMY 22 | MARCH/APRIL 2024For the latest news and analysis go to www.motorship.com
8 The first two 700 teu pure-electric container ships are on order for COSCO Shipping Development at CHI
8 Tomas Tengner. ABB Marine and Ports


LearnfromC-suitekeynotepanel

ErThamWaiWah ChiefSustainability Officer
TheMaritimeand PortAuthorityof Singapore(MPA)


DiscussingPortsandShipping-collaborationtoachieve2050goals

DrSanjayKuttan ChiefTechnology Officer
GlobalCentrefor Maritime Decarbonisation (GCMD)

LarsRobert Pedersen DeputySecretary General BIMCO

Sponsoredby:
Supportedby:



CaptainK. Subramaniam GeneralManager PortKlang Authority


AntonisMichail WPSPTechnical Director International Associationof Portsand Harbours(IAPH)

EvaLiu Headof Shipment Product OceaniaMarket Maersk
Programmeoutnow-Booknow
Gaininsightsfromindustryexpertson:


GreenShippingCorridors
InfrastructureDevelopment

Futuremarinelowandzero-carbonfuels
Bunkeringinfrastructure
GreenFinance
GreenTechnologies
MaritimeDigitalisation








Itisamust-attendeventforpolicymakers,portsandterminaloperators, shippingcompanies,shippersandlogisticscompanies,fuel&propulsion providers,classificationsocietiesandassociateddecarbonisationclusters.
Forfurtherinformationaboutspeaking,sponsoringorattendingasa delegate,contacttheEventsteamon: +441329825335
info@greenseascongress.com
greenseascongress.com
Mediapartners:




Mediasupporters:






#GreenPortsandShipping
A FUTURE IN THE MAKING
Among a clutch of companies giving effect to the concept of an unmanned ship, robotic subsea technology exponent Ocean Infinity has commissioned a flotilla of offshore vessels specifically designed for eventual remote control from ashore. writes
David Tinsley

The new 78m Armada series offers a multi-role capability, with the accent on geophysical survey, geotechnical sampling, and inspection, maintenance and repair (IMR) services.
The investment in the eight-ship class, as with the other strands of the Armada fleet development programme encompassing 21m, 35m and 85m designs, is complemented by the creation of a remote control centre (RCC) network and proprietary remote communications system.
Thus, while each vessel has a relatively small crew complement, the ground is being laid for a future wherein all operations and navigation will be handled by the onshore establishment of mariners and specialised personnel at workstations. Clearly, the project is long-term not only in vision but also in expectation of profitable returns, given the premium entailed in initially coupling crewed vessels with an infrastructure conceived for ultimate, fully remote control. Furthermore, the diesel-electric newbuilds have been engineered to facilitate adaptation over time to new fuels and lessened environmental impact.
Ocean Infinity’s strategic objectives expressed in the Armada programme at large have a potentially broader industrial benefit, in testing the mettle of shipyards, engineering companies, equipment suppliers and designers in providing solutions to visionary requirements. A degree of public funding support in the UK has enabled certain facets to be realised or progressed.
The eight Armada 78 vessels were contracted from
Norwegian international shipbuilder VARD, and specified with diesel-electric battery hybrid power and propulsion. Vessel construction was assigned to the group’s Vung Tau yard in Vietnam, with certain installation work undertaken at VARD’s Soviknes premises in western Norway. Production at Vung Tau of the last of the series, the Armada 78 08, was completed towards the end of January this year.
Developed in conjunction with Ocean Infinity’s US and UK technical personnel, the VARD 9 60 design is a multi-purpose platform distinguished not only by its provision for ‘lean’ crewing and remote control, but also by the preparation for alternative fuels such as ‘green’ ammonia and fuel cell and battery technologies.
VARD’s standing as an integrated shipbuilder was a significant factor in attracting the ground-breaking Ocean Infinity contract. Besides the capability of its international shipyard network for marrying lower-cost construction in Vietnam with a high-technology specification, the group’s VARD Design brought its extensive know-how in high-grade offshore vessels to bear on the project, while VARD Electro supplied the shipsets of SeaQ advanced marine electronics. VARD Accommodation provided the accommodation solution, and VARD’s daughter company Seonics delivered the moonpool launch and recovery system.
The dialogue between Ocean Infinity and VARD had first centred on three larger ships. However, over time, the project changed in form to one entailing eight smaller vessels, resulting in the 78m class. Because of the vessels’ planned
8 Ocean Infinity’s build programme of eight 78m multi-role offshore vessels has recently been completed
ELECTRIFICATION & AUTONOMY 24 | MARCH/APRIL 2024 For the latest news and analysis go to www.motorship.com
Credit: Ocean In fi nity
PRINCIPAL PARTICULARS - Armada 78 01
Length overall 78.0m Length bp
Breadth 15.0m
Depth 7.0m
Draught 5.3m
Gross tonnage 2,373t
Deadweight 1,490t
Deck cargo capacity 1,000t+
Propulsion system Diesel-electric battery hybrid
Main generator engines 2 x Cummins QSK60-M + 2 x Scania Dl16M
Battery packs 2 x 565kWh
Main propulsion thrusters 2 x Kongsberg US205
Speed, maximum/cruising 14kn/10kn
Manoeuvring thrusters (bow) 3 x Kongsberg TT1650FP
Class DNV
Class notations +1A, Battery(Power), CLEAN, COMF(C-3, V-3), DK(+), DYNPOS(AUTR), E0, Fuel ready(Ammonia[D; P}), NAUT(OSV), Recyclable, SF, ER(SCR)
Registry Singapore
long lifespan, the contractual owner was predisposed to investing more in each ship, and the ultimate design was arrived at through many iterations by VARD.
The Armada 78 series supports operations with the owner’s remote-operated vehicles (ROVs), seabed drills and cone penetration test (CPT) systems. The aft bulwark is removable so as to permit deployment of the Ocean Infinity autonomous underwater vehicle(AUV) fleet. Each vessel incorporates two 9m x 4m moonpools fitted with modular launch and recovery systems(LARS), fully automated and remotely-operable from the company’s present remote control centres in Austin, Texas, and Southampton, UK.
The robotic undersea equipment carried by the Armada 78 vessels can include Hugin 3000/6000 AUVs rated to 3,000m and 6,000m depths, Saab Seaeye Leopard ROV, and Saab eWROV and Schilling HD WROVs.
The ships thereby have the wherewithal to undertake a range of services including detailed mapping and survey tasks, analysis and inspection of seabed assets, and seabed search, salvage and subsea security. In addition, given the spacious open deck area for payloads of up to 1,000t of equipment or containers, the vessels can provide a logistic function, and carry out asset maintenance operations.
The power and propulsion system is of diesel-electric battery hybrid type. While the two Cummins QSK60-M engines and two Scania Dl16M units that drive the four main generators run on diesel fuel, the vessels’ design and engineering arrangements have been conceived to evolve through various stages of future fuels implementation.
The QSK60-M high-speed engine, manufactured at Cummins’ Daventry plant in the English Midlands, is a 16-cylinder vee-form four-stroke offering power ratings from 1,491 to 2,013kW. The Scania Dl16M eight-cylinder vee-type covers a power band up to 846kW.
Classed to DP2 dynamic positioning standard, each vessel has two Kongsberg US205 main propulsion thrusters and a troika of Kongsberg TT1650 bow tunnel thrusters. The current propulsion configuration can deliver a maximum speed of 14 knots and a cruising speed of some 8-10 knots, and the power arrangements include 1,130kWh of energy storage capacity by way of two banks of 565kWh Corvus Orca lithiumion batteries.
ELECTRIFICATION & AUTONOMY

Preparation for fuel upgrades is reflected in the provision of two large tank spaces and fuel cell rooms, and in the DNV Ammonia Ready notation. In fact, Ocean Infinity is leading a project that secured UK government innovation funding for building a marine propulsion test facility with an integrated ammonia marine propulsion system. The test facility will demonstrate clean-fuelled technology eventually capable of powering Armada vessels using an ammonia-based fuel cell system. The company’s partners in the undertaking include Oxford Green Innotech (OXGRIN), University of Oxford, and the University of Southampton’s Marine & Maritime Institute.
Cummins’ UK arm has subsequently won UK research funding for a collaborative project addressing the development and deployment of a methanol conversion kit for the QSK60 engine series. Under the R&D endeavour, Ocean Infinity is to provide one of the Armada 78 vessels as the platform for Cummins to design, develop and test the dual-fuel methanol and hydrotreated vegetable oil (HVO) technology.
While construction of the 78m series was under way, Ocean Infinity augmented the VARD orderbook in February 2022 through a contract for six newbuilds of an 85m version. Embodying the VARD 9 80 design, the vessels will be optimised for inspection, maintenance and repair(IMR) and light construction work in the offshore energy market. Provision will be made for the integration of fuel cell and battery technology in keeping with the company’s lowcarbon service mantra.
The company’s establishment of RCCs in Southampton and Austin represents the start of a network that will include stations in Singapore, Tasmania and elsewhere.

8 Ocean Infinity plans to begin integrating its geotechnical equipment, such as the Infinity CPT 250, onto its Armada vessels in 2024
8 Ocean Infinity successfully carried out deep push seabed cone penetration tests remotely in an industry first as part of its work conducting subsea surveying tasks for a Scottish floating offshore wind project, it announced in November 2023
For the latest news and analysis go to www.motorship.com MARCH/APRIL 2024 | 25
72.3m
ELECTRIC POWER GAINS MOMENTUM IN FERRY INDUSTRY
Next year it will be a decade since the first battery powered ferry, the aptly named Ampere, started operations on domestic, short haul service in Norway

A lot has happened in the meantime and it is now widely assumed that electric power would be the answer to the demands of green transition when it comes to short haul vessels.
The use of battery power at sea took a major leap forward recently, when Buquebus placed an order with Incat Tasmania for catamaran fast ferry on services on the River Plate: the 130 metre long vessel will be able to carry 2,100 passengers and 226 cars and have a battery pack of some 40MWh, four times bigger than anything that has gone to sea before.n The ferry, which will have a speed of 37.5 knots, is scheduled to be delivered in 2025, had originally been intended to run on LNG.
Meanwhile, DFDS, the Copenhagen based ferry and logistics operator, unveiled at a capital markets day event near the end of 2023 that the company plans to have six new vessels in service between 2024 and 2030. Two of these would be battery powered ropax vessels that would operate in the Dover Strait between the UK and France. This follows an agreement between the company and the ports of Dover, Port Boulogne-Calais and Dunkerque Port too decarbonise the maritime traffic in the Straits. “A sufficient power supply on land and infrastructure to accommodate recharging facilities in ports are equally important to be able to complete the fleet electrification,” DFDS said in a statement in October last year.
Indeed, the land based facilities can play a major role in the practical execution of ferry projects based on the use of battery power. Stena Line, the Swedish ferry giant, recently decided switch focus from a battery and solar powered Stena Electra design to a new concept design called Stena Hydra, which as the name would suggest, is based on hydrogen fuel cell technology.
Charging infrastructure poses challenges
The first named design that was earmarked for the Gothenburg - Fredrikshavn service, called for a 215 m long vessel with 3,100 lane metres for freight and accommodation for 1,200 to 1,500 passengers. It would have required 70MWh of battery power capacity for the 50 mile crossing. It had been intended to enter service by 2030.
Stena Hydra, meanwhile, has a length of 212 metres and lane metre capacity of 2,500. Its superstructure is much smaller than that of Stena Electra, indicating a significantly lower passenger capacity. With a 10 ton net hydrogen load, it is expected to have a range of 150 miles. The hydrogen fuel cell installation would have an output of 25 MW and the electric motors would deliver 20MW, Swedish Environmental Research Institute says in a report on the new concept, adding that this would offer the lowest round trip costs.
“The reason that Stena Elektra is currently a vision rather than a concept is that the (land based) infrastructure isn't there yet. Few ports, let alone regions, have what it takes to charge a fully electric ferry. Charging infrastructure is crucial for this technology to be viable, so we are in dialogues with authorities and other external stakeholders around the infrastructure needed prior to moving ahead with this project,” Maria Hellbjörn, PR & Communications Manager at Stena Line, told The Motorship.
Scandlines in Denmark have, however, been able to move ahead with the land based power installations and as a result, its battery powered ropax new building called Futura that is currently under construction in Turkey is due to enter service between Rodby Havn in Denmark and Puttgarden in Germany this year. Two existing vessels have already been converted as hybrids and Scandlines plans to operate the service without direct emissions as the remaining two will undergo a similar conversion.
This will entail charging the 10 MWh battery packs on each vessel that have a cruising speed of 18.5 knots to 80% of full charge in just 12 minutes while the vessels are in port. Both ships are expected to have been converted by some time 2025 and the total investment in decarbonising the route would amount Ito EUR 31 million, Scandlines said in a statement.
Norwegian Electricity Systems will deliver a 30MVA grid transformer and other equipment and Scandlines recently signed a contract with a German utility company to receive power for its installation in Puttgraden. In Rodby Havn, a charging facility has been operational since 2022.
Kristian Knaapi, Sales Manager at the Finnish consultant naval architect firm Deltamarin that is involved in the ferry market, said that the outlook in the electric ferry business is
ELECTRIFICATION & AUTONOMY 26 | MARCH/APRIL 2024 For the latest news and analysis go to www.motorship.com
8 Buquebus electric ferry
Incat Tasmania
Credit:

encouraging - he described the market as booming - but a lot would depend on two things, the development of shore based infrastructure on one hand and battery technology on the other.
Combination of batteries with other green energy sources an option
“If a ship should rotate between ports A, B, C and A, a it is a big open question if there will be charging capacity for batteries to allow it to do this,” he told The Motorship. Many passenger carrying ferries shuttle just between two ports, but the picture changes considerably in the case of freight only roro vessels, which are often used on services that include calls in several ports.
One way forward in extending the range of electric ferries could be combining batteries with wind assisted systems and e.g. solar panels and this approach could also be used to minimise the use of diesel engines in cases when they could not be eliminated from the power train, he said.
The development of more powerful and also lighter battery packs will drive the development of electric ferries. Currently, the weight of battery packs is a consideration that needs to be taken into account when designing a ship as these need to be placed low in the vessel, for stability reason. Their weight will also reduce the dw- capacity of the ship.
Ice conditions will pose challenges of their own as a ship needs a lot more power to push through ice than what is the case in open water conditions. This means that a service like the crossing between the Finnish and Estonian capitals, a distance of about 51 miles, that might otherwise be well suited for an electric ferry in the future, may not be among the first busy, short haul ferry services of such length to employ a ferry relying on battery power.
The cost of electricity can vary even significantly between various ports in a single country and there is little ports can do to effect the price, said a report published by Lighthouse, the Swedish Maritime Competence Centre, in 2018. It also warned that in some cases, an investment made in power supply from ashore can become unprofitable or that the price of electricity will discourage such an investment.
Ferries have led the way in the development of the use of
electric power at sea and according to a report by IDTEchEx in the UK, 37% of all battery installations for marine use in capacity terms delivered in 2019- 22 went for use on these types of ships. Norway, perhaps unsurprisingly, was the biggest market, with some 100 electric ferries now in service. The report forecast that hybrid cargo vessels would emerge as the next major development of electric power at sea.
Most of the ferries that operate in Norway are in use on short crossings e.g. across a fjord, which allows their battery packs to be charged easily and quickly. Domestic short haul services have led the way of the use of battery power elsewhere as well.
Study finds major potential for electric ferries in China
In China, a study made in 2021, showed that on five key coastal ferry services, more than half of fossil fuel emissions could be replaced by electric ferries, Xiaoli Mao, Elise Georgeff, Dan Rutherford, and Liudmila Osipova said in a report published by the International Council of Clean Transportation. In the Pearl River, the figure is highest, at 95%, followed by the Hainan Strait (92%) and Yangtze River Delta (74%). For the Bo Sea, the figure was 61% and Taiwan Strait 56%.
“The analysis finds that current battery technologies can already satisfy most application scenarios for China’s coastal fleet. Most ferry legs in coastal China are shorter than 200 km, which is well within the battery range values of most ferries studied. Battery technology improvements would help electrify other more difficult segments of the existing ferry operations, namely larger ropax ferries deployed on longer routes,” the authors say.
Higher charging power would help to improve the continuity of ferry operations using batteries, which is crucial for application scenarios where one route is exclusively served by one ship. “If policymakers wish to prioritise better electric ferry deployment, they may wish to focus first on electrifying smaller ships and shorter legs. Electrifying passenger ferries up to 55 m that sail on legs up to 100 km could replace 50% of fossil fuel use with electricity. For ropax ferries, the same fossil fuel replacement target can be attained by targeting ships up to 170 m in length traveling on legs up to 200 km,”
For the latest news and analysis go to www.motorship.com MARCH/APRIL 2024 | 27
8 Stena Hydra
ELECTRIFICATION & AUTONOMY
Credit: Swedish Enivronmental Research Institute
4-STROKE ENGINE MAKERS EXPAND METHANOL OFFERINGS
The solutions available for methanol engines and retrofit packages are growing, but there are still financial concerns about their viability
April will see MAN Energy Solutions fire up its 4-stroke seven-cylinder 51/60 test engine in Augsburg configured for methanol combustion. Type approval is expected in Q3 2025, followed shortly after by a first pilot installation, the details of which are being finalised.
As a retrofit, the MAN 51/60R-DF-M engine will have lowpressure, pre-mixed (Otto) combustion via the installation of a port fuel injection (PFI) system. This injection system is simpler and more robust than the high-pressure diesel direct injection based on diffusive (Diesel) combustion that will be used for new-built engines like the MAN L/V 32/44CR MeOH ready or the MAN 49/60. It will have an operating pressure of a maximum of 50 bar compared to 800-1,000 bar for the high-pressure injection.
The high-pressure technology, which will enable engine operating with highest methanol shares in all load ranges, will be introduced later to retrofits. For now, the methanol retrofit kit for the 48/60 engine will involve conversion to a well-proven 51/60 engine type including an optimized combustion chamber (cylinder head, liner and piston) and a methanol map ranging from 25% to 85% with less than 3% diesel, making it comparable in performance to other MAN dual-fuel engines. Beyond 85% engine load, the percentage of diesel will be higher, possibly up to 50%.
Bernd Siebert, Head of Retrofit & Upgrades at MAN PrimeServ in Germany, says the retrofit requirements will involve new components throughout the engine, with mainly just the engine block and crankshaft remaining as original. This is partly due to the bore change but also because of changes required to the injection system, turbocharger, air cooler and automation system to ensure a safe and optimized methanol operation. “It is a big investment, and the overall investment for the vessel is even higher with tanks, fuel supply system and piping. But finally our customers will get back an like-new engine after the methanol conversion contributing to decarbonize the maritime industry.”
Siebert highlights that MAN is working with industry partners, including shipyards and class, to streamline retrofits as much as possible while still meeting the high safety requirements required to protect people and assets. “The target for retrofits is to spend as little time as possible in drydocking. The vessel modifications can be undertaken even if methanol is not yet available, and we have packages with all the technical specifications needed ready to hand over to customers today.” He urges shipowners not to wait too long as resources for engine builders and shipyards are limited given the high demand from shipowners taking action on CII requirements.
For engines more than 15 years old, it may not end up being an economical retrofit, and Siebert suggests that MAN’s diesel efficiency kits like the latest Lifecycle Upgrade retrofit product are another option for meeting CII requirements as they reduce fuel consumption and emissions by around 10-12%.
For newbuilds, MAN is currently concentrating on 4-stroke methanol-ready engines, including for the 175D and

49/60DF, with the newbuild engines expected to be available by 2027.
Expanded portfolio
Wärtsilä will introduce another four methanol engines to its portfolio this year: Wärtsilä 20, Wärtsilä 31, Wärtsilä 46F and Wärtsilä 46TS. This is in addition to the Wärtsilä 32 methanol engine already launched. The company is also developing the corresponding methanol retrofit capabilities, including for the Wärtsilä 31, Wärtsilä 32, Wärtsilä 46F, Wärtsilä 46TS and Wärtsilä ZA40S engines.
The Wärtsilä 20 engine range will cover a power range of approximately 1-2MW and is expected to be available for genset applications late 2024. It will feature low-pressure (30-40 bar) PFI for the methanol fuel. While low pressure means the methanol/diesel share is lower than the higher pressure injection used in larger engines, maintenance time is expected to be the same as if the engine was running on gas or distillate fuels. Product manager Johan Kålax says the choice of PFI was a trade-off between lower installation and operating costs and performance. Regarding engine price, he says: “You don’t see a big difference between, for instance, a dual-fuel gas engine and this methanol engine, but the big difference is outside the engine where we are talking about maybe up to 40% lower initial cost for building the whole installation setup.”
The Wärtsilä 31 Methanol engine range builds on the highly efficient 31 technology introduced in 2015. The power range will be 5-10MW per engine. It will be available for delivery as a genset or main engine in Q1 2027, but the methanol-ready solution is already available, and due to the modular design, upgrade to methanol operation will be streamlined. Although it is a second engine in the same medium bore engine space as the Wärtsilä 32, it will be offered with more and different cylinder variants and in a higher power range.
The Wärtsilä 46TS is the company’s newest engine range, providing power in the large bore 7-22MW range and suitable
8 Wärtsilä has announced plans to introduce another four methanol engines to its portfolio this year
METHANOL & AMMONIA 28 | MARCH/APRIL 2024For the latest news and analysis go to www.motorship.com
for a wide range of propulsion and vessel types. It will be the first platform to have the new high-pressure, multi-fuel injection system that is expected to bring power density equivalent to a diesel engine and able to handle a methanol share of above 95%. Due to its modular design, the 46TS will be suitable for conversion from diesel or gas to methanol, says Federico Bottos, Wärtsilä 46F product manager. “The 46TS was built with modularity in its roots.” A pure diesel version of the engine will also be launched this year.
The Wärtsilä 46F Methanol engine range will also have a high-pressure injection system and efficiency equivalent to that of a diesel engine. This engine is adding the ability to run on HFO as well as methanol to the large bore portfolio and will be available for delivery from 2026.
Fuel storage
SRC introduced its Methanol Superstorage to market at the end of 2023. The storage increases fuel tank volume by over 85% while having little impact on general arrangement. The motivation comes as it takes around 2.5 times the methanol to achieve energy efficiency equivalent to HFO. A 16,500 TEU container ship - typically 366m long and 51m wide - would lose 300 TEU to provide the extra fuel storage needed to sustain conventional bunkering patterns, according to Alphaliner.
Tanks storing low flashpoint fuels on board ship conventionally requiring cofferdams of at least 600mm across to separate internal and external walls as a safety precaution. Instead, Methanol Superstorage features 25mm thick tank walls formed by sandwich panel system technology that consists of a continuous polymer core injected between two steel surfaces. The patent protected steel-polymer-steel barrier has been approved for permanent repairs by IACS class societies for over two decades, including for corrosion in ship structures. Class laboratory tests of the polymer core have verified chemical resistance - including for methanol.
Financial viability
The question of the financial viability of choosing methanol as a fuel has been evaluated in a new report from Lloyd’s
METHANOL & AMMONIA
The 46TS was built with modularity in its roots ‘‘
Register (LR) which has found that the total cost of ownership (TCO) for passenger ships retrofitted with methanol dual-fuel engines to be more than double the cost of blended fuel (Blend B30), heavy fuel oil and HFO with onboard carbon capture and storage technologies (CCS).
Fuel for thought: Methanol for Passenger Ships examined the TCO for operators over a 15-year period and based results on a calculation that 65% of voyage time would be spent in EU waters.
For retrofits, the report states that “Costs include engine rebuild, piping, fuel system, tank coating, as well as design, planning and drydock costs. Indications suggest that engine and fuel system costs, which will be most of the overheads, could be in the range of 10% to 25% of a vessel’s value.” Also, the costs of rebuilding an engine need to be carefully evaluated given not all engines will have a test engine equivalent to ensure it meets emissions testing requirements under IMO regulations.
Overall findings identified in the report, based on analysis by the LR Business Advisory team, show the bunkering price of methanol to be the main commercial barrier for its adoption, with the use of less environmentally friendly fossil based (grey) methanol a more commercially attractive proposition for passenger shipowners than a blend of 50% grey, 25% bio- and 25% e-methanol, even when EU emissions taxes are taken into account.
However, the study highlights that methanol is a technically viable fuel for ship operators looking to reduce the carbon emissions of passenger ship newbuilds, owing to the similar characteristics of methanol to existing fuels. Viable retrofit paths have also been taken to the sector, such as the pioneer LR project for the Stena Germanica back in 2015. This technical viability is reflected in the global orderbook with passenger ships ranging from small inland vessels to the largest cruise ships awaiting delivery.
8 The use of the SPS Technology Sandwich Plate System offers a potential solution to space penalties in fuel tank capacity during methanol retrofits

For the latest news and analysis go to www.motorship.com MARCH/APRIL 2024 | 29
SAFETY AND SUPPLY KEYS TO MARINE DECARBONISATION
Dr Olivier Denizart, Technical Manager at Lubmarine, shares some of the key findings on Lubmarine’s latest R&D projects on future fuels including experiments on an Ammonia-fuelled engine that it has modified – and the critical importance that safety will have to play in shaping the implementation of new fuels
The last 18 months has seen the global shipping industry really start to accelerate its decarbonization journey.
LNG is now recognized as a mature and best immediate option to help reduce shipping’s CO2 emissions today, whilst at the same time providing the technological platform for the transition to new fuels including Biofuels, Ammonia and Methanol.
As the speed of new fuel development ramps up, the challenge for lubricant manufacturers is to stay ahead of those changes to ensure that, when those fuels do become commercially viable, we have lubricant solutions available that are tried, tested and ready to support our customers as we evolve towards a carbon-free future.
From its inception over 70 years ago, Lubmarine has always embraced a pioneer spirit with the goal of developing and delivering market leading marine lubricants. And as we enter this multi-fuel future, this ethos remains at the forefront of our development – with a significant investment in our own R&D and a willing and active commitment to crossindustry collaboration.
Along with Methanol, Ammonia has been recognized as a viable fuel solution, one that, whilst offering opportunities towards GHG reduction targets, also poses key challenges from the perspectives of safety (both environmental and human) and practicality. Providing good combustion in a dual fuel engine, another advantage to shipping is that Ammonia should face less competition with other areas of the transport sector – unlike some of the other fuel alternatives being considered.
Ammonia storage already exists in 120 ports globally, enabling both ship to shore and ship to ship bunkering solutions alongside reasonable liquefaction temperatures. But it is far from plain sailing when it comes to Ammonia with significant challenges around its volumetric energy density and of course its deadly toxicity and the need for stringent safety solutions.
At the same time OEMs are developing NH3 engines with MAN ES and WinGD anticipating it will launch a two-stroke Ammonia fuelled engine in 2024.
It’s a fuel solution we are actively researching here at Lubmarine, with our R&D teams having redesigned a 1.5 litre passenger car diesel engine to run on Ammonia enabling us to run our own in-house tests to better understand the impact that Ammonia will have on engines and specifically for us, the impact, and challenges for effective engine lubrication.
With any new fuel, we must understand the interactions and impacts of the relationship between lubricant, fuel, and engine to ensure that our lubricants are delivering the desired performance and,
p to action mes to Ammonia its volumetric dly and g t will launch a 024 arching ams car ng er will us, ive tand the and s are and,
through lifecycle assessments, be assured that there will be no carbon generation.
It’s a methodology that starts in our labs with our Ammonia engine oil development project.
Our Test Approach
From an initial perspective, we wanted to show that NH3 can interact with lubricant chemistry so our challenge is to fully understand its operating behaviours to enable us to adapt lubricant formulations to meet specific needs.
When it comes to lab testing, our key objective is to develop an engine oil technology that allows reliable, clean, and efficient use in Ammonia-fuelled internal combustion engines.
To meet these objectives, we need to:
4 Observe - lubrification challenges in a real engine environment - deposits, wear, corrosion, oil ageing.
4 Evaluate - sensitivity to engine oil composition.
4 Calibrate - laboratory test severity.
Our challenge is to understand the impact that NH3 has on oil components and their performances, the availability of NH3 ICE tests (performance, endurance), access to large engine prototypes and our need to run and understand evaluation test results.
Key observation and assessment areas when we are running Ammonia engine tests include:
Ammonia dilution; Nitro-oxidation; Corrosion; Cylinder wall degreasing; Water handling; Deposit control; Material/ Elastomer compatibility
Testing protocols look at three specific areas:
4 – inclu
4 Oil formulation – including base oils and additives. NH3 Alteration Tests – influence of temperature and crankcase gases composition.
4 Alteration Tes c
4

Performance evaluation
2024 will be a very key year for us here at Lubmarine with regarding to lubrication development to reflect new fuels.
2024 will be Lubmarine w t
Thanks to ou start
Thanks to our R&D and OEM‘s partnership we’ll start lubricating tug boats using an Ammonia-fuelled 4-stroke engine this year.
8 Dr Olivier Denizart, Technical Manager at Lubmarine
On the Me Methanol 2ou been able character have be engines Wha our te on the invalu evalu tests
On the Methanol side, we are starting trails with Methanol 2-stroke commercial engines.
From our lab test results to date we have been able to analyse the oxidation and main characteristics of our lubricants where they have been adapted to Methanol-fuelled engines.
What we have been able to do is widen our testing to incorporate actual field tests on these new engines which is providing invaluable data from which we are able to evaluate, implement and apply to further tests to support product development.
METHANOL & AMMONIA
30 | MARCH/APRIL 2024For the latest news and analysis go to www.motorship.com
CHEAPER SUPPLY AND REGS NEEDED TO SUPPORT MeOH USE
Wallenius Wilhelmsen, the Oslo based PCTC and logistics group, has doubled an order for 9,350 CEU capacity Shaper class methanol dual fuel ammonia ready vessels at China Merchants Jinling Shipyard (Jiangsu) Co., Ltd to eight, with a further four units still under option.
“They will also be ammonia-ready and able to be converted as soon as ammonia becomes available in a safe and secure way. These next generation vessels will play a key role in the introduction of Wallenius Wilhelmsen’s net zero emissions end-to-end service by 2027,” the company said in a statement.
“Together with our customers we are committed to further shaping our industry and accelerating towards net zero. These new vessels are a vital part of that journey,” Xavier Leroi, EVP & COO Shipping Services at Wallenius Wilhelmsen, said in the statement. The first of the Shaper Class vessels are expected to be delivered in the second half of 2026 and the four additional vessels should enter service between May and November 2027.
While many shipping companies are placing orders for vessels capable of running on green fuels, the uptake of these is likely to remain slow due to supply and cost concerns. “At the moment, the questions whether owners will be able to buy these fuels and if yes, at what price, remain,” said Kristian Knaapi, Sales Manager at the Finnish consulting naval architect firm Deltamarin that was in charge of basic and detail design work of the Shaper class ships.
However, making ship ready for these new fuels can mean fitting them outright with the necessary equipment or reserving space for the equipment in the design of the layout of the vessel. Either case will make it cheaper to take the step to the use of alternative fuels at a later point than not preparing the ship for this at the design stage.
Customers so far agreed to pay for costlier, green fuel As fas as the willingness of customers to pay for more expensive green fuels, Wallenius Wilhelmsen’s experience so far is encouraging.
“It is correct that greener, low GHG fuels are more expensive than conventional fuels. While we expect this price premium to reduce over the long term with increased supply, without advancement in production processes and regulatory developments aimed at bridging the cost gap, the premium will remain relatively high in the near term, said Lene Bårli Wiederstrøm from the group’s Orcelle Accelerator team, who are responsible for work with biofuels and future fuels.
“Wallenius Wilhelmsen’s experience so far, is that customers are willing to pay for emission reductions, currently based on using biofuel. We are committed to contributing to a low carbon future and will be a shaper on the journey to net zero,” she told The Motorship.
“As such we are continuously working on new ways to improve the energy efficiency of our vessels, by exploring alternative fuels, promoting regulation that enables decarbonisation in shipping to occur at scale and at shape, and by looking at different mechanisms to reduce the cost gap both within our organisation and through external mechanisms. We believe the introduction of carbon price

mechanisms are essential for bridging the gap between conventional and low carbon fuels,” she concluded.
Meanwhile figures from Clarkson Research in London show that 45% of newbuilding orders in gross tonnage terms placed in 2023 were designed to run on an alternative fuel125 of these being for methanol dual fuel ships.
Incentives lacking for use green fuels
The reason the transition to lower or zero carbon marine fuels will take time is that there is little incentive for a transition, said Robin Meech, Managing Director at Marine and Energy Consulting Limited in the UK. The green fuels are very expensive - green LNG $2,000 more costly per ton of fuel oil equivalent, according to one estimate.
“Increasingly legislating for ships to be greener globally can only be achieved through the IMO where political wrangling is delaying such regulation as everybody sees the cost,” he told The Motorship.
“Current EU carbon equivalents are at about €50/ton to $55/ton. A ton of FO (fuel oil) emits 3.1 tons CO2, hence the additional cost of ‘paying’ to pollute is $170/ton of fuel oil. With VLSFO (very low sulphur fuel oil) above $600/ton this is an absorbable cost,” he said, adding that some may see this as the way forward in the shorter term, out to 2030 when the carbon price will rise as the available credits are reduced.
The shipping industry - and the bunker supply side - are notorious for not complying or running very near the rules. The expansion of the dark tanker avoid sanctions on Russian oil is a case in point. These dark tankers are still being bunkered by the market. There is unlikely to be much more growth in the market for conventional, fossil fuels but global demand of over 250 million tons is still very likely in 2030, he concluded.
that some may see this horter term, out to will rise as the d the bunker us for not ar the rules. ker fleet to il a case rs are still ket. There is in the l fuels but illion



METHANOL & AMMONIA For the latest news and analysis go to www.motorship.com MARCH/APRIL 2024 | 31
8 Shaper class PCTC
8 Kristian Knaapi
BALLAST WATER: MEPC 81 STRUGGLES TO DELIVER CLARITY
Several years ago, it was thought the ballast water management (BWM) market would experience a boom, rewarding the cutthroat behaviour of many OEMs with a massive influx of orders and a winner-takes-all profit outcome

But as it stands, the boom has appeared more a protracted trickle, and the regulation surrounding the issue is still in flux. As of the conclusion of MEPC81 in March, a number of important questions had still not been settled.
When it comes to systems’ effectiveness, of major concern is the fact that replacement parts are not up to snuff. Though a system’s OEM might be one of the relatively few to survive a decade’s consolidation, and may have already had both IMO and USCG type-approval for some time, and shipowners are finding that the companies providing replacement hardware – bulbs, filters, piping – are changing constantly. Another vexed question is, like Theseus’ ship -how many replacement parts can be fitted to a system before it is no longer the one originally type-approved?

obsolete components, an improved component, or an installation-specific required component,” can lead to some challenging situations, the document indicates.
One is that that OEMs – as represented in the submission – are left scratching their heads as to why their systems being found non-compliant. Solving this problem, BEMA says, would eliminate some of this guesswork and provide a solid basis for continual development. BEMA also said that changing the rules would add capacity for continuous improvement of installed systems.
A submission to this year’s IMO meeting of the environmental protection committee (MEPC81) by the Ballast Water Equipment Manufacturers Association (BEMA), asks the IMO for a resolution to this. Namely, it is hoped that the IMO will, like the US Coast Guard (USCG) type approval procedure, require a ‘bill of materials’ (BOM), to specify which filters, pumps and valves are appropriate for a given system.
“…A change in component availability, discontinued or
“BWMS manufacturers may seek to improve their equipment based on operational experience gained and/or industry demands, such as ways to address ballast water management in ports with challenging water quality (CWQ) or improving energy efficiency,” it said.
If adopted, perhaps this will begin to address a problem that has been plaguing the industry for some time – that no matter how good their designs, and how successfully they managed to pass type-approval testing, there is apparently zero guarantee of future performance, or future compliance.
At the outcome of MEPC81, this remained an open question. “Due to limited time to discuss all the necessary changes,
BWTS 32 | MARCH/APRIL 2024 For the latest news and analysis go to www.motorship.com
8 A scientific paper in New Microbes and New Infections asserted that ballast water might be contributing to the transmission of new antimicrobial resistant (AMR) bacteria, or superbugs
amendments… were not concluded,” said LR in its MEPC 81 post-match analysis, adding that “…a more permanent solution to be developed as part of the BWM Convention review.
“As such it is anticipated that this will be worked on intersessionally, and further concrete proposals were invited to be submitted to MEPC 82, with a view to finalisation of the guidance,” LR said.
Although the IMO granted final type-approval for two additional BWM systems – Techcross’ ECS Hychlor 2.0, and NK’s Blueballast II Plus NK-03 at MEPC 80, and basic approval for Erma First’s Flow BWMS at MEPC 81 -- even those ballast water systems with the highest type-approval standards available today are proving, on occasion, to be ineffective.
Bridge over troubled waters
‘Ports with challenging water quality’ came under discussion at MEPC 81, where the IMO adopted new guidance to assist shipowners in keeping their systems functional. It is by now well-understood that UV Irradiation systems encounter issues with light penetration in brackish water, requiring a good deal more power to perform correctly. This is a common issue in the Great Lakes, and in ports that are some way upriver.
But in February, the result of an Australian study conducted over several years, showed that out of 39 ships calling at the Ports of Gladstone, Dampier, Walcott and Newcastle, more than a third – some 36% -- were non-compliant with the IMO D-2 performance standard. In discouraging news for proponents of electro-chlorination (EC) the preferred solution for larger vessels as well as the alternative usually considered for UV systems, almost all those involved in the Australian sample used active substances, making for a rather poor indictment of the industry as a whole.
The non-compliant organisms tended toward the large, the study found. “All observed non-compliances were found in the largest size class of organisms in the discharge standard,” the study determined – the ≥50μm size bracket. “This outcome shows, as other studies have, that organisms in the ≥50 μm size class are more prone than other size classes to present a risk of non-compliance in treated ballast water.”
On top of this, some 5% of the samples didn’t comply with standards based on total residual oxidant (TRO), suggesting that not only did the systems perform badly in the role for which they were designed, but polluted the marine environment beyond acceptable levels to boot. “The range of concentrations released across the various BWMS that utilise active substances could be of potential environmental concern,” the study determined, given the number of volume of active substances released into the environment.
However, on a positive note, the study noted that a degree of improvement had been observed since 2021, with both


biological and chemical non-compliance incidences showing an incremental decrease in the years since.
The IMO issued new guidance at MEPC 81 for dealing with challenging water quality, including recommendations for maintaining effective operation, steps for identifying when a system is not operating correctly, and how to make record of and communicate with local authorities in the event of a noncompliance issue.
A people problem
Another factor in non-compliance could be crew familiarity, Optimarin has suggested. Not only are poorly-trained crews more likely to be unsuccessful in compliance with the rules; but, according to Optimarin, could even be a factor in the sector’s reliance on spare parts.
We see that a lot of start-up issues with new systems could be avoided simply by including crew training in the planning phase ‘‘
“We see that a lot of start-up issues with new systems could be avoided simply by including crew training in the planning phase,” said Optimarin system engineer Øystein Myhrvold. “It is also an ongoing process to ensure crew have the knowledge they need during service visits to minimise the need for maintenance.”
Tests on two different vessels with identical equipment, but two different standards of training, demonstrated intriguing results. “By providing training for the crew, we saw consumption of spare parts and other wares could be reduced significantly, thereby saving money,” said Optimarin service manager Arne Lund. “If the operator understands the system and knows how its components work, this makes it possible to anticipate and quickly resolve issues so the BWTS can run effectively with low maintenance costs over many years.”
By way of a solution, Optimarin is offering online courses and even simulator training to help bring crew up to speed. The scheme, OptiLearn, adds to familiarisation training conducted at the time systems are installed.
In apparent acknowledgement of this need, the IMO noted that as part of an upcoming review of the STCW code, seafarers should be given new familiarisation training for compliance with the BWM Convention. If Optimarin is correct,
8 Review pending: the review of the BWM Convention will be worked on intersessionally, in the expectation that the guidance will be finalised at MEPC 82
BWTS For the latest news and analysis go to www.motorship.com MARCH/APRIL 2024 | 33
this training should pay for itself in the long run, by lengthening the life of equipment, as well as reducing offhire costs from non-compliance.
Tabled at MEPC 81 was a submission requesting that IMO de-mystify the rules surrounding the use of an onboard back-up ballast water system. If a portable system is carried and used as a back-up in the case the installed system failed, is it to be considered a newly installed system once it is commissioned?
Following disputes between ship operators and port state control authorities on the issue, IMarEST submitted a document to IMO to consider this question. “[The] industry has developed a variety of innovative solutions and technologies to assist ships in cases when a contingency measure is needed,” it said.
It has become commonplace for ballast water OEMs to release containerised versions of their systems, with Damen and Bawat being the standout examples. Carried on the deck of a ship, ballast lines would need to be connected to these systems, bypassing existing piping. This approach is hardly optimal from the point of view of power consumption, since it requires that large volumes of seawater be pumped up onto the deck during ballasting or deballasting operations. But with the systems installed below decks seeing such high failure rates, it is hardly surprising that some shipowners are willing to pay for such an option, in a pinch.
“These scenarios may include an installed BWMS becoming temporarily inoperable, a ship encountering challenging water quality (CWQ), ballasting operations in emergency situations, or use on ships that cannot practically install a BWMS permanently,” IMarEst added. However, it criticised a “lack of clarity in the existing regulations and lack of relevant guidance,” from IMO. Portable BWMS systems “… have been considered as permanently installed by some flag States and/or recognized organisations.”
The lack of regulatory clarity over whether a back-up system constituted a separate installation, then, was holding back more widespread adoption, IMarEST said. “The demand for these contingency measure options is currently low, influenced by the regulatory gap that exists and which creates uncertainty for shipowners about the acceptability of their use.”
Unfortunately, it appears they will have to wait until MEPC 82, or even 83, for clarity.
New momentum
But it may be that BWM systems are about to take on a welcome new degree of urgency. A paper submitted to the scientific journal New microbes and new infections reveals that ships’ ballast water might be contributing to the

transmission of new antimicrobial resistant (AMR) bacteria –or what is known is superbugs.
“…It is plausible that clinically relevant bacterial pathogens and their genetic determinants, emerging in a specific country, could be also silently introduced to other countries through [shipping’s] transoceanic pathway,” the paper, entitled Criticalpriority resistant bacteria hidden in ship ballast water: A challenge for global epidemiological surveillance, read.
Indeed, this may have already happened, the paper asserts. An AMR-strain of E-Coli, originally found in Brazil in 2016 where it has infected humans and plants, has since spread to Europe and Asia, “being early identified in Brazil in bivalves used as marine sentinels of anthropogenic pollution of ecosystems associated with the largest international Latin America seaport.”
Although speculative in nature, the paper “draw[s] attention to the need for epidemiological genomic investigation for tracking [World Health Organisation] critical priority bacteria in BW.”
“Therefore, the global scientific community and environmental authorities should work towards developing strategies to monitor and strengthen the surveillance of AMR through transoceanic activities,” the authors determine.
If it is true, the spread of AMRs in ballast water is already posing a threat to animals and humans on land, and could play a role in future pandemics. This alarming development may be what is needed to finally push the ballast water management convention over the line.

8 The IMO issued new guidance at MEPC 81 for dealing with challenging water quality, including recommendations for maintaining effective operation
8 A submission requesting that IMO de-mystify the rules surrounding the use of an onboard back-up ballast water system could not be considered at MEPC 81
BWTS 34 | MARCH/APRIL 2024 For the latest news and analysis go to www.motorship.com






REGISTER NOW



11
13 TO
For more information visit: seawork.com contact: +44 1329 825 335 or email: info@seawork.com
Seawork celebrates its 25th anniversary in 2024!
The 25th edition of Europe’s largest commercial marine and workboat exhibition, is a proven platform to build business networks.
Seawork delivers an international audience of visitors supported by our trusted partners.
Seawork is the meeting place for the commercial marine and workboat sector.
Discover 12,000m2 of undercover halls that feature plant and equipment on the quayside and pontoons.
Experience
operating at high speed for security interventions and Search & Rescue.
June
in partnership with
Celebrate innovation and excellence in the commercial marine industry at The European
Learn from the industry experts through the Conference programme, that helps visitors to keep up to date with the latest challenges and emerging opportunities.
Opportunities at the Careers & Training Day on Thursday 13 June 2024 that delivers a programme focused on careers in the commercial marine industry.
JUNE Southampton United Kingdom
partner MARITIMEJOURNAL COMMERCIAL MARINE BUSINESS
#Seawork Media
NUCLEAR SHIPS – WHAT HAS BEEN ACHIEVED TO DATE?
Of all the technologies developed over the last 150 years, nuclear power is arguably the one that has singularly failed to live up to its utmost potential. That applies to most industries including shipping where in commercial terms nuclear power never really took off

Exactly why that should be the case is open to conjecture, but there have been a very few attempts to bring shipping into the nuclear age. Before exploring those, it is important to understand a little about the history of nuclear physics.
Mankind has had an understanding of elements dating back to ancient times, but atomic theory was by all accounts the brainchild of the Greek philosopher Democritus in around 400BC. For most of the next 2,000 years scientific interest was in categorising elements and searching for means to convert one into another. At the beginning of the 20th Century, Albert Einstein suggested that breaking down the nucleus of an atom would release energy.
Not all were convinced but some where and in 1932, physicists John Cockcroft and Ernest Walton split the atom for the first time and confirmed the theory. The focus of attention had by now moved from transmuting or creating new elements to harnessing the energy of the atom. As with many innovations, military use was one of significant interest. HG Wells had even predicted this as early as 1914 in the novel The World Set Free where the plot includes description of atomic warfare that renders cities unliveable for years.
X-heading
Scientists may have made other uses of nuclear energy, but it was the atomic bombs dropped on Japan towards the end of WW11 in 1945 that grabbed public attention and likely concentrated minds on the extreme hazard of nuclear energy. From 1945 onwards, four nations, Great Britain, USA, USSR and France – ironically the four permanent members of the UN Security Council – all involved themselves in
developing nuclear weapons. After the Cold War began in 1947 a whole generation was to grow up under the cloud of a nuclear Armageddon.
After his election as President of the USA in 1952, Dwight D Eisenhower delivered a speech at the UN which has become known as Atoms for Peace. It was an attempt to move nuclear development away from purely military purposes to more peaceful aims although without much planning for how this could be practically achieved.
By 1955, the year in which USS Nautilus, the first ever nuclear submarine, was launched, US officials were well aware that nuclear power would not be a tool of economic development for years, if not decades, to come, and the remainder of the Eisenhower administration was marked by experimentation in how civilian nuclear technology could be used as a tool of foreign policy.
Which is where the first civilian nuclear ship, Savannah, had its genesis. Eisenhower wanted to showcase peaceful uses for nuclear energy and hit upon the idea of a ship which could take a nuclear reactor around the world allowing people and foreign governments to witness a demonstration of nuclear power that they might not otherwise understand the potential for.
It took four years to build and cost almost $50 million. Launched in 1959, Savannah did not follow the development of nuclear warships and featured a civilian standard reactor using low-enriched uranium and with considerable emphasis on safety and reliability. It would be another three years before the reactor was installed and declared fit for service.
Although the ship had a small cargo capacity it was more of a propaganda platform with luxurious passenger
NUCLEAR POWER 36 | MARCH/APRIL 2024 For the latest news and analysis go to www.motorship.com
8 Ulstein Thor envisaged as a nuclear powered replenishment at sea vessel for battery powered cruise ships and yachts
Credit Ulstein
accommodation and public spaces. It sailed for three years in this configuration before being converted entirely to cargo carriage.
The 13,599GRT Savannah was 181.66m in length and with a beam of 23.77m. The reactor was a pressurised water type rated at 74MW and operating at 120 Bar. All nuclear reactors are nothing more than a source of heat. The heat is used to produce steam by means of heat exchangers to drive a turbine which in turn produces electricity. On a ship, the turbine could be used through a gearbox to give direct mechanical drive in the same way that conventional steam turbine powered ships were configured. Savannah had a 15.1MW propulsion turbine driving the single mechanical linked propeller. The vessel had a top speed of 24kt and a service speed of 21kt.
X-heading
The high pressure needed for the cooling water system in Savannah and later ships is considered a hazard. By contrast a modern gas carrier operates at pressures up to a maximum of around 20bar but much lower if refrigerated as well.
Between 1965 and 1968, Savannah demonstrated one of the prime benefits of nuclear power for commercial vessels. In that period, it sailed over 300,000 nautical miles without any need to refuel. It was eventually refuelled in 1978 and continued to sail for another three years before being laid up.
The ship has been shifted several times since and undergone needed repairs but has never sailed commercially since. There have been several proposals for its future use as a museum or hotel. In 2023 MARAD announced in would finally fully decommission the ship and remove the reactor after which proposals for future use would be considered.
The next nuclear cargo ship was the 14,000dwt bulk carrier Otto Hahn commenced in 1963 by Howaldtswerke Deutsche Werft in Kiel, Germany. After being launched the in 1964 it was 1968 before the ship's 38MW nuclear reactor which operated at 80 Bar was taken critical and sea trials began. In October 1968 the ship was certified for trading but did not load its first cargo until 1970 having been used in the intervening period for research purposes. Between 1968 and 1972 the ship covered 250,000 nautical miles using just 22kg of Uranium fuel.
In 1979 the ship’s nuclear service ended having clocked up 650,000 nautical miles. After the reactor was removed and conventional diesel power installed, the ship began a second career in 1983 as a container carrier. Otto Hahn ended its life on the beach at Aland in 2009.
X-heading
Leaving aside the nuclear icebreakers built by the USSR and later Russia, only two other non-military nuclear ships were ever built. The Japanese vessel Mutsu and the USSR ship Sevmorput. Mutsu was built as a general cargo ship but never traded. She was completed in 1972 but after a minor incident during her testing phases was effectively laid up before being converted to the diesel electric research vessel Mirai in 1996 after the reactor was removed. The vessel is still operational in this form.
Sevmorput can perhaps claim to have the most successful career as a commercial vessel. Built originally at the very end of 1988 as a LASH carrier the ship has more recently been operated as a container ship. At 260.3m in length and with a deadweight of 34,615 it is the largest of all the four commercial vessels built. It is also the most powerful with a 135MW reactor operating at 40bar. .
The vessel operated mostly in the Russian Arctic although it did make several international voyages to Vietnam and

more recently from the Russian arctic around to St. Petersburg. The ship had a near nine year break in operations between 2007 and 2016 when it was variously reported as to be decommissioned or converted to a nuclear drill ship for use in Russian Arctic waters. However, on its return to service in 2016 it was used for transport of containers and has continued in this service since. In December 2023, when the vessel was almost 35 years old it suffered a small fire when in port although this was said not to have been nuclear related and no safety issues were raised. It has been rumoured that the ship will be decommissioned in 2024 but this has not been confirmed. Information about the ship’s operational distance covered is not available but it has been said that refuelling has only taken place three times in the vessel’s lifespan to date.
X-heading
The four vessels mention above the only ones with a nonmilitary purpose. Their record is not particularly impressive beyond the distances sailed and number of refuelling operations but then they were conceived and constructed when operational demands on ships and ship sizes were very different from today.
In 1979 the ship’s nuclear service ended having clocked up 650,000 nautical miles ‘‘
Far more military nuclear vessels have been built with over 700 surface vessels and submarines having been constructed. Their safety record is generally good although eight nuclear submarines have sunk, and one was scuttled. The last incident involving a nuclear submarine was in 2003 and involved a decommissioned craft under tow. No surface vessels have been lost.
Overall it would be fair to say that even though all of the vessels employed pressurised water reactors, the safety record has been very good. For the proposed new generation of commercial vessels, the technology used will likely be different and with an ever lower level of risk.
The next chapter looks to be opening soon but is probably a decade away yet. If Sevmorput is indeed decommissioned, the time between its retirement and the first of the next generation nuclear commercial vessels will be the only time since 1965 that no commercial nuclear vessels have been in existence if not fully operational.
NUCLEAR POWER For the latest news and analysis go to www.motorship.com MARCH/APRIL 2024 | 37
8 Nuclear reactors such as this may be the future power source for commercial ships
Credit Core Power
PREPARING FOR THE NEXT GENERATION
Many believe the time is ripe for a new generation of ships to hit the water and with a change in technology finally deliver the promise of nuclear as envisaged almost a century ago

The first generation of nuclear ships were small compared to today’s specialised ship types and utilised a source of power that was generally perceived as dangerous. That perception has at least been proved wrong in the more than 60 years that have passed since the Savannah became operational.
Furthermore, the Pressurised Water Reactor (PWR) used to date in all nuclear ships has a safer alternative in Molten Salt Reactors (MSR) which are what is envisaged in all of the projects currently underway. MSRs – of which there are numerous variations were first developed in the 1950s and intended as the propulsion system of a nuclear-powered bomber. That early project was abandoned in favour of PWRs possibly because MSRs do not produce weapon grade nuclear material while PWRs can and in the nuclear arms race, weapon grade material was essential.
There are numerous projects underway to develop new generation nuclear ships and in all probability they could become ready long before appropriate new regulation is in place. In anticipation of a nuclear ship future, the IMO adopted Resolution A491( XII) - the CODE OF SAFETY FOR NUCLEAR MERCHANT SHIPS in 1981. This however outdated and does not take into account changes in nuclear technology since it is composed around the use of PWRs.
X-heading
In December 2022, the UK Maritime and Coastguard agency acknowledged this shortcoming in MGN 679(M) section 1.6 where it states that ‘the Code should be reviewed as
necessary to ensure it captures technological progress’ and also ‘There is currently no confirmed information from the IMO on when the next formal review of the Code will be. The Code itself lists reasons for a review; however, it does not specify how frequently the Code should be updated’.
On the development front, UK-based Core Power is arguably the front runner in the field of commercial nuclear ships is developing a variety of MSR known as a molten chloride fast reactor along with its partner TerraPower and others. After 11 years of work on the project, it is anticipated that a micro experimental reactor of the type now being built will be switched on in 2026. If all goes according to plan, Mikal Boe, CEO of Core Power the UK-based organisation believes that commercial versions could be ready in the 2030s. That is a time scale that Professor Jan Emblemsvåg of the Norwegian University of Science and Technology (NTNU) agrees with.
Emblemsvåg has been involved in the Norwegian NuProShip project which has been studying three reactor types for use in commercial shipping. That work has encouraged Norwegian shipbuilder Ulstein Verft to develop a concept design called Thor which could be powered by a thorium reactor. Thorium is a quite abundant element but is only mildly reactive until bombarded with neutrons and then produces Uranium 233 for the reaction. Uranium 233 is not a weapon grade product.
Boe, recognises that appropriate regulation will be key to ensuring their acceptability. He makes the point that under current rules, a mechanically linked steam turbine propulsion
NUCLEAR POWER 38 | MARCH/APRIL 2024 For the latest news and analysis go to www.motorship.com
8 NS Savannah, world’s first nuclear commercial ship en route to World Fair 1962
Credit Nuclear Regulatory Commission
system would be considered a nuclear installation, but a nuclear electric system would be permitted. There is a small power loss in electric systems, but this is easily overcome because the reactor would provide more than sufficient power with just a tiny increase in fuel.
Looking at the advantages for owners and operators, there is likely to be a weight saving advantage with Boe estimating the weight of a nuclear reactor, its concrete containment system and the ancillary equipment is around 70% that of a comparable diesel engine. Doing away with the fuel tanks allows for more cargo space.
Both Boe and Emblemsvåg put the additional space as a small percentage overall with Boe suggesting around 4.5% additional space on a 185,000dwt Capesize bulker. That equates to around an additional revenue from 8,000 tonnes of freight earning cargo on top of the zero cost for bunker fuel.
X-heading
Furthermore, in an electric propulsion system, the reactor could be placed anywhere in the hull with just the electric motors and gearbox at the stern. This would allow for optimising the ship configuration for enhanced hydrodynamic performance.
Boe believes that nuclear electric also has a less obvious benefit. “As well as decarbonisation ships, a nuclear electric vessel could help decarbonise ports. Using reverse cold ironing, the power of the nuclear reactor could be made to power shore cranes, conveyors and other cargo handling gear while the vessel was being worked”.
He also believes that is a powerful argument in persuading ports to accept nuclear vessels which is something that may need to be done if nuclear vessels are to become acceptable.
The safety of MSRs is due to many factors including they operate at pressures lower than 5 Bar reducing risk of failure, the fuel and coolant salts are chemically inert, the boiling point of fuel salt is about 1670K or more, much higher than

the operation temperature 973K. Therefore, the pressure of primary system cannot increase, and the risk of explosion is therefore reduced or eliminated. Even if a radiation leak does occur, any spread is likely to be limited to just 20m or so rather than the several kilometres of a PWR. That means that for a large ship with a beam of over 40m, all radiation would be contained inside the protective concrete housing.
Convincing the ship operating sector of the benefits of nuclear is possibly the easiest hurdle to overcome. Boe points to a recent online poll conducted by a maritime news service. Of the 197 respondents, 49% said that nuclear power will definitely be a viable alternative, and another 21% were positive that nuclear power will play a role, but only in the longer term. On the other side, 13% said they saw no role for nuclear power as a viable alternative for ships. The remaining 17% thought nuclear power was an unlikely fuel for commercial shipping. He also highlights that of Core Power’s 65 shareholders, the majority are either ship operators, shipbuilders or financial institutions that will be financing the commercial nuclear fleet.
Nuclear ships – the benefits
Ships today must comply with more regulations on emissions and efficiency than at any time in the past. Until the year 2000 when the NOX Tier I level became effective and 2005 when the Baltic SECA came into effect, ships were not subject to any emission regulation at all although the future limits for SOx and NOx had been set in 1997. Then in 2015, thee EEDI rules began limiting CO2 emissions.
Apart from any auxiliary generators on board, a nuclear ship would be unaffected by any of the emission rules. With emission charging (EU ETS scheme) now beginning, nuclear ships would be outside of those charges.
Since power limitation is often a consequence of meeting EEDI or EEXI rules, ship speed generally has been reduced significantly in recent times. At the turn of the century when containerships operated at 25kt there were plans and projects for even faster ships to come into service. The Maersk B class of 4,196teu Panamax ships built from 2005 were part of this
movement with a service speed of 29kt and a maximum of 37kt. The ships are still in service but today operate normally at around 14-16kt.
A nuclear powered ship would have no speed limitations except for safety reasons in congested areas and could thus bring about the speed revolution once envisaged. Sailing at economic speed would become a thing of the past.
A ship built with several years or even a lifetime of fuel supply on board would be spared the necessity to take bunkers into account when calculating cargo capacity for daily operations. More to the point most of the bunker capacity would be freed up for cargo although some additional ballast tanks might be advisable for stability purposes. The cost of delays for bunkering would be dispensed with.
Nuclear ships can also assist in solving the latest environmental focus of biofouling. This often occurs when ships are idle for long periods or laid up. In times of low demand, laying up ships could be avoided
as the vessel could sail aimlessly in circles without wasting fuel. This would ensure that fouling does not accumulate and so help prevent transfer of species.
Faster ships would mean fewer ships are needed for the same volume of trade. That would mean less need for newbuilding capital and better profitability for ships. It would also help address the seafarer shortage. Taking that point further, as the reactor would be maintenance free, fewer engineering crew might be needed. The propulsion system and things such as steering, ballast treatment, electrics and the like would be much as on conventional ships. Oily bilge water might also be expected to be less of a problem.
Geopolitical events have been a feature of recent months. Whilst there would be an initial period of disruption if something like the attacks on shipping in the Red Sea occurred, the rerouting of ships and the ability to increase speed would minimise the delay and of course no additional bunkering would be required.
NUCLEAR POWER For the latest news and analysis go to www.motorship.com MARCH/APRIL 2024 | 39
8 Sevmorput –Russian LASH/ Container carrier was still in service in 2023
Credit Terskii Bereg
REFINED BOSS CAP LOWERS CAVITATION, BOOSTS EFFICIENCY
Driven by a research partnership, the Holy Boss Cap is a hydrodynamic solution that delivers multiple benefits for ship owners face increasingly tough regulatory requirements and rising operational costs, writes
Dr Batuhan Aktas, CEO of EcoMarine Innovations
To comply with the International Maritime Organization’s EEDI, EEXi and CII requirements, all ships must meet specific energy requirements for their size and type. The EEDI, which became law for all ships in 2013, is not prescriptive about what methods are used to achieve compliance, creating many opportunities for innovative design.
One area of ship operations that has attracted much attention in recent years due to the possibilities it represents for emissions reduction is that of cavitation. During ship operations, cavitation occurs because of vortices that build up and cause bubbles to collapse under the ship’s propeller. The results of this process include increased noise, vibration and energy usage. The latter is of particular concern for ships looking to streamline their energy profile.
Existing energy saving designs for propeller hub caps or boss caps incorporate fins that act to improve vessel efficiency by reducing cavitation while ships are at sea. However, the finned design generates turbulence and is linked to cavitation as bubbles form underwater.
At EcoMarine Innovations, a pioneering start-up supported by the University of Strathclyde, we set ourselves the goal of addressing these issues while we were working on a project with a major European propeller manufacturer. During this collaboration, we learned that cavitation is a major cause of inefficient ship operations, accounting for 3-8% of lost propulsive efficiency.
Convinced that it must be possible to develop a better way of addressing this efficiency cost and the related environmental impacts, we studied the design of boss caps commonly used on ships. In the course of this research, we began exploring the idea of designing a boss cap that utilises holes instead of any structure that can cause turbulence or operational risk. The result is the Holy Boss Cap (HBC).
Testing the technology
The development of the HBC demonstrates the importance of research support of the kind we have at Strathclyde University. The product, which was launched in February 2024, eliminates propeller hub vortex cavitation, the main source of rudder erosion, and reduces associated propeller efficiency losses. However, an early version of the innovative ‘holy’ design failed to gain traction as it was not hydrodynamically efficient, as the holes reduced the efficiency of the propeller.
The revised design of the HBC, which we implemented following extensive studies in partnership with the University, addressed these problems with carefully placed and angled holes bored into a conically shaped hub. The holes channelled into the hub affect the high pressure in the hub vortex by redirecting the flow downstream. The resulting low-pressure swirl flows in the opposite direction to conventional hubs, behind the propeller blades, reducing propulsive drag, fuel consumption and maintenance costs.
To assess the effectiveness of the new design, we carried out computational fluid dynamic (CFD) tests on a typical

twin-screw vessel with V-brackets and a 90m coastal general cargo ship. Using local workstations running parametric optimisation software combined with CFD software, we studied the effects of variables such as chamber volume and profile, number of holes, and angle of the holes.
When we compared the HBC with more advanced energyefficient boss caps currently in operation, we found that it to be at least 3% more efficient. Overall, compared to standard propeller boss caps, the HBC improved propeller efficiency by 3.1% and thrust by 1.1%, while reducing torque by 2%, rudder cavitation by 10%, and propeller induced noise by 1-3dB. We expect the HBC to be capable of delivering increases in propulsion efficiency of up to 5%, compared to conventional propeller boss caps.
These potential savings were further confirmed by a reputable European cavitation tunnel testing facility, where savings more than 2.1% were found despite challenging scale effects.
Given the pressing emissions-reduction challenges that the shipping sector faces, we believe it is not enough to develop a solution without ensuring that it can be scaled in a meaningful way. Having successfully completed validation tests at a hydrodynamic research centre in Sweden, the HBC is undergoing ship model basin trials to verify the efficiency gains on larger commercial and naval vessels. Meanwhile, the patent for the HBC is pending, with the support of Strathclyde University in the patent application process.
A simpler solution
It has become clear to us while developing the HBC that traditional methods of addressing ships’ energy wastage have failed to keep pace with the industry’s needs, or to consider the wider impacts of underwater noise and vibration. Zero propeller hub vortex cavitation can help towards ESG,
8 Dr Batuhan Aktas, CEO of EcoMarine Innovations
DESIGN FOR PERFORMANCE 40 | MARCH/APRIL 2024 For the latest news and analysis go to www.motorship.com

EEXI and CII goals, improve efficiency and reduce the costs associated with cavitation induced rudder erosion. Driven by research, the HBC is meeting this need in the market and is contributing to more sustainable ship operations.
We are delighted that CFD trials have validated the HBC concept. Underpinning our efforts in bringing this product to market is the drive to find the simplest way to address what is actually a very simple problem. We have achieved this by several metrics: installation of the HBC takes just five to six hours, and the product can easily be retrofitted or installed on new vessels. Once fitted, the product can be maintained during routine drydock visits. In addition, the HBC offers reduced CAPEX compared to existing devices. Thanks to the ease of casting and the lower amount of material required, it






costs significantly less to manufacture than current conventional propeller hubs.
The business case for shipowners is compelling. Taking the example of a 250m vessel and a fuel consumption of about 35 tonnes per day, operating for approximately 240 days a year, and assuming a 3% saving return on investment is around five months.
We have already received significant interest from ship owners and propeller manufacturers and are engaging with potential partners to take the concept to market.
8 Dr Aktas is the CEO of EcoMarine Innovations, Futureproof Ship Design Group at the University of Strathclyde, Glasgow, Scotland.





8 Far left: Conventional hub vortex cavitation is a major cause of inefficient ship operations, accounting for 3-8% of lost propulsive efficiency. Left: The Holy Boss Cap eliminates propeller hub vortex cavitation, the main source of rudder erosion, and reduces associated propeller efficiency losses
Hosted by:











For the latest news and analysis go to www.motorship.com MARCH/APRIL 2024 | 41 Coastlink is a neutral pan-European network dedicated to the promotion of short sea shipping and intermodal transport representing shipping lines, ports, logistics companies, terminal operators, cargo handlers, and freight organisations. For more information on attending, sponsoring or speaking contact the events team: visit: coastlink.co.uk contact: +44 1329 825335 or email: info@coastlink.co.uk #Coastlink 2024 Programme and Topics The short sea shipping and sustainable logistics network Book now Delegate place includes: • 2-day conference attendance including lunch & refreshments • Technical Visit • Electronic documentation • • Short Sea ShippingAdvancing supply chain resilience with modal shift Smart operations - Digitalisation, Automation, & Innovation Green corridors - collaboration to drive sustainable growth Gold Sponsor Sponsors: Media partners: GREENPORT INSIGHT FOR PORT EXECUTIVES MOTORSHIP MARINE TECHNOLOGY THE Supporters:
DESIGN FOR PERFORMANCE
APRIL Port
Amsterdam The Netherlands 24 25 TO
of
HYBRID COASTER SERIES FOR NORDIC OWNERS
A new generation of 5,400dwt coasters introduced by a Finnish-owned Swedish company is claimed to cut CO2 emissions per cargo unit by as much as 50%, relative to existing vessels of similar size, writes
David Tinsley

The investment programme implemented by Finnish dry bulk specialist ESL Shipping through its Swedish short-sea subsidiary, Ystad-based AtoB@C Shipping, is remarkable both for its scale, entailing 12 newbuilds, and for the innovative nature of the design involved.
The project also signifies a further advance in the export market for Indian shipbuilding contractor Chowgule & Co, from whom the entire series was ordered in three tranches, the initial six-ship commitment worth EUR70m ($77m) having dated from September 2021.
Attributed with an electric-hybrid power train, the multipurpose type employs a fuel-flexible diesel main engine, complemented by a substantial battery pack enabling fuelsaving, zero-emission port stays, manoeuvring and peak shaving. Dubbed the Green Coaster generation, the design and model testing was undertaken in conjunction with the Dutch company SMB Naval Architects & Consultants.
The Cyprus-flagged Electramar has given first form to the class, and is set to make her debut in northwest European trade. Commissioning of second-of-class Stellamar is imminent, while the third newbuild, Ecomar, was launched at Chowgule’s Goa premises two months ago, paving the way for final block assembly of fourth-in-line Aquamar. Handover of the final vessel in the 12-ship series is expected by mid 2026.
In an alternating delivery sequence, six of the 12 newbuilds are for AtoB@C itself, while the other six will be owned by institutional and private investors, fronted by Green Coaster Shipping, also of Ystad in southernmost Sweden. The entire series is destined for the pool of the same name, under the commercial management of AtoB@C.
The 90m vessels are suited to the transportation of a wide variety of bulk goods and breakbulk products, and are strengthened to Finnish/Swedish ice class 1A standard and for loading and discharging aground at tidal berths.
The arrangement of the bridge and accommodation
forward has optimised the hull envelope for revenue earning, and the long, unobstructed deck allows for more deck cargo and longer items of project freight compared to that possible with the company’s existing vessels. The ship’s configuration, and the compactness of the machinery spaces, is claimed to have yielded up to 20% more cargo capacity than coasters of similar dimensions.
The single, box-like hold provides a total cargo volume of 7,650m3 and incorporates three movable bulkheads and the means of providing partial tweendeck subdivision along nearly half the hold’s 60m length. The tanktop is reinforced to 15t/m3 overall and for 20t/m3 in a loading pattern. The underdeck cargo spaces are closed by pontoon-type hatch covers, creating a flush, obstruction-free weatherdeck.
The main engine is from the medium-speed portfolio of Yanmar, a marque well known for its reliability, robustness and comparative simplicity. The nominal maximum output of 1,920kW meets the requirement for the modest laden speeds in the coastal and short-sea traffic, while manoeuvring at tight berths and in restricted channels is assisted by a 300kW bow thruster.
The main propulsion machinery will run on low-sulphur fuel and is also able to burn various renewable fuels or diesel blends such as the Neste marine 0.1 co-processed fuel produced at Neste’s Porvoo refinery in Finland.
Dependency and expenditure on auxiliaries and the associated fuel consumption is lessened through the adoption of a battery pack. The Corvus Energy-supplied battery installation provides an energy storage capacity of nearly 1MWh. The ‘plug-in’ nature of the system means that the batteries can be charged from the shore when alongside, as an alternative to being re-energised by the main engine when under way.
Energy storage and the attendant electric drive solution provide for peak shaving, or delivering boost power in ice
8 Cutting a new figure in the European short-sea trades, the Indianbuilt Electramar
SHIP DESCRIPTION 42 | MARCH/APRIL 2024For the latest news and analysis go to www.motorship.com
SHIP DESCRIPTION

conditions, feeding the ship’s net when berthed or at anchor, and potentially also allow for port entries and departures to be made solely on battery power. Moreover, electricity can be drawn from the landside grid at suitably equipped quays and jetties, obviating the need to run a genset. The overall nature of the arrangements not only lessens fuel usage and atmospheric emissions, but also cuts down on noise disturbance for port communities.
Hoglund’s Integrated Automation System (IAS) seamlessly links alarm monitoring, control and power management systems. The IAS integrates with Hoglund’s cloud-based ship performance monitor (SPM) using data from the automation system to oversee performance in real time.
Founded in 2000, AtoB@C deploys ice-classed short-sea carriers in the 3,000-6,000dwt range, mainly shipping woodpulp, steel products, scrap, sawn timber, and other bulk commodities plus project cargoes. The company has been part of ESL since 2018 and is increasingly engaged in contract of affreightment traffic.
A recent endorsement of the Green Coaster philosophy encapsulated by the new series was expressed in a new transportation contract signed with Finnish stainless steel producer Outokumpu. The agreement will see AtoB@C Shipping cover more of the import and export traffic generated by Outokumpu’s Tornio steel mill in northern Finland.
Besides improving efficiency in the steelmaker’s supply chain, use of the Electramar class is expected to reduce voyage emissions by 40% per cargo ton relative to current vessels. Outokumpu’s environmental agenda is to realise a reduction in direct and indirect emissions of 42% per ton of stainless steel by 2030, from the 2016 baseline.
Furthermore, AtoB@C and Outokumpu are looking to use the Virtual Arrival concept as the standard operating practice whenever possible. Virtual Arrival entails adjusting ship speed in accordance with berth availability at the destination port, so as to save fuel and achieve correspondingly lessen emissions. At the end of last year, AtoB@C said that Virtual Arrival had enabled the shipping company to cut voyage emissions by 10% where the system had been applied.
The company’s new vessels are presently exempt from the Carbon Intensity Indicator (CII) and EU emissions trading regulatory edicts due to the design’s gross tonnage measurement (4,200t) lying below the 5,000gt threshold. However, with an eye to the future, and so as to provide
transparency for customers, AtoB@C has taken the initiative in establishing an internal reporting system whereby emissions and the CII rating are calculated for each ship.
Execution of the Green Coaster programme denotes the attainment of a new technological level by Chowgule & Co, building on the Indian group’s extensive track record in producing dry cargo vessels for the North European shortsea owner community. The order benefited from a financial assistance scheme offered by the Indian Government to shipbuilders.
The subvention arrangements took effect in 2016 and are due to run until 2025. At the time when AtoB@C’s Finnish parent booked the initial tranche of six newbuilds, in 2021, the scheme covered 17% of the contract price or the adjudged ‘fair’ price, whichever was the lower as determined by international valuers.
8 AtoB@C Shipping has signed an agreement with stainless steel producer Outokumpu to handle more of the seaborne logistics for the Tornio steel mill (pictured) at the northern end of the Gulf of Bothnia. The Electramar class is expected to reduce voyage emissions by 40% per cargo ton relative to current vessels, contributing towards Outokumpu’s target of lowering emissions per ton of stainless steel by 42% by 2030, compared with 2016 levels
For the latest news and analysis go to www.motorship.com MARCH/APRIL 2024 | 43 PRINCIPAL PARTICULARS - Electramar Length overall 89.95m Length bp 84.95m Breadth 15.95m Depth, moulded 10.05m Draught, maximum 6.10m Gross tonnage 4,135t Deadweight, all-told 5,424t Deadweight, carrying capacity 5,082t Cargo volume 7,650m3/271,500ft3 Holds 1 Movable bulkheads 3 Main engine power 1,920kW Battery pack 994kWh Bow thruster 300kW Class LR Class notations General cargo ship, Unrestricted navigation, Bottom-strengthened for loading/unloading aground, *IWS, ECO, *LMC, UMS, Electric hybrid(PM, PB, ZE), BWTS, Cleanship, Green Passport, Ice Class 1A Registry Limassol/Cyprus
BOUND FOR DUTY ON THE DOGGER BANK
Illustrative of accelerating investment in the offshore market’s commissioning service operation vessel (CSOV) category, Norwegian interests are introducing a new generation intended to raise the bar in wind farm support, writes
David Tinsley

Constructed in China to the order of Oslo Stock Exchangelisted Integrated Wind Solutions (IWS), the 90m IWS Skywalker is the outcome of a technical project shaped by a drive for second-to-none, year-round operability, personnel safety and environmental profile.
Encapsulating the walk-to-work concept, the vessel will act as a mothership for technicians attending offshore wind turbines. She has been designed specifically to support commissioning works during the construction of wind farms and to enable subsequent through-life servicing of both bottom-fixed and floating turbines. The industry’s move to increasingly powerful and larger turbines, and the development of field arrays further offshore in demanding environmental conditions, is reflected in IWS’ tailor-made class.
IWS Skywalker made her transit to Europe from the Jiangsu shipyard of China Merchants Industry Holdings (CMI), arriving at the Danish port of Hanstholm during February for final preparations before commencing her initial contract at the Dogger Bank Wind Farm in the North Sea. Five further newbuilds of the class, embodying the Kongsberg UT 5519DE design, are scheduled to be completed by the Chinese contractor over the course of 2024 and into 2025.
Equipped with 3D motion-compensated gangway and motion-compensated crane for safe transfers of personnel and equipment, to ensure operational continuity in the rigours of the central North Sea, the vessel type is also distinguished by a double-ended hull form and novel

propulsion thruster arrangement for precise manoeuvring and position holding. Although constructed as a plug-in hybrid, a substantial battery installation will provide for a degree of all-electric, zero-emission operation.
The IWS Skywalker breed is among the first in the sector to achieve the DNV Silent (E) notation, which acknowledges measures implemented to reduce underwater radiated noise so as to minimise impact on marine life.
The vessels are built around a technological backbone afforded by a comprehensive equipment solution supplied by Kongsberg Maritime. This includes permanent magnet(PM) azimuth thrusters, generators, electrical and control systems, a fully integrated bridge with navigation, dynamic positioning (DP) and automation systems, and deck machinery.
Main propulsion is provided by four Kongsberg US255series azimuth thrusters, two forward and two aft, each with a top-mounted PM electric motor. The three main generator sets are driven by rugged, high-speed engines from the Caterpillar portfolio, in the shape of 12-cylinder, vee-type 3512E diesels.
The shipowner attributes its new breed with “the largest battery packs in the industry”, in an offshore service context. Supplied by Corvus Energy, the installation is understood to amount to a capacity of 2.2MWh. Solar panels are fitted on the vessel as an additional charging source. While allowing for limited all-electric propulsion, such as navigation in port areas, the energy storage system is on a scale that provides
8 Walk-to-work offshore: CSOV operability at the highest level in IWS Skywalker
SHIP DESCRIPTION 44 | MARCH/APRIL 2024For the latest news and analysis go to www.motorship.com
Credit: MarineTra ffi c.com/Vitalii Bondarenko
SHIP DESCRIPTION
a usable reserve with the scope to facilitate transition to more extended electric operation. An offshore charging infrastructure would open up new opportunity in this regard.
IWS Skywalker can accommodate up to 120 personnel, comprising 30 crew and up to 90 clients, in a total of 92 cabins. The motion-compensated, electrical gangway system affords technicians a direct connection between the ship’s superstructure and each turbine, and can be positioned at reach heights of 10m to 32m. Deployment will be generally assured in conditions of up to 3m significant wave height.
The 3D compensated, Colibri knuckle boom crane can lift equipment and material from the deck to a fixed or floating turbine at up to 32m height, and may potentially also be used for subsea operations. Both crane and gangway were designed and supplied by Cargotec’s MacGregor division, whose contract included a remote control station on the bridge.
The 400m2 open deck area aft is complemented by 420m2 of warehousing, with temperature- and humidity-controlled storage, IMDG stores and workshops.
The stern is fitted with a special structure for stepless boat landing from crewboats working with personnel on the wind farm. The ship also carries a 12.5m daughter craft, launched and recovered by davit, and and which has capacity for 12 technicians plus two crew. The 25-knot craft can also be used to ferry material or equipment for turbine upkeep and repair. The heli deck mounted forward gives added dimension to the ship’s capability for personnel and spare part transfers.
The interior spaces have been configured to comply with DNV’s COMF (V-2, C-2) notation, acknowledging the fundamental importance of habitability and comfort to the ultimate efficiency and wellbeing of personnel onboard. Such considerations also have longer-term implications for factors such as crew retention and charterer favour.
IWS Skywalker has been chartered by the Dogger Bank Wind Farm development consortium for service during the first two phases of construction (A and B), involving commissioning of 13MW turbines of GE’s Haliade-X type. This will engage the ship until the end of the first quarter of 2025, and possibly beyond if an option on an additional period is exercised. In addition, IWS has a 304-day CSOV charter contract for the C-phase, effective from the third quarter of 2025. Dogger Bank C will have arrays of the more powerful 14MW model of the Haliade-X series.
Underscoring the considerable role of offshore wind in the UK’s energy transition strategy, completion of the three phases of the major scheme on the isolated sandbank in the southern North Sea will provide a total 3.6GW of renewable energy capacity. At its closets point, the wind farm will be 131km (about 80 miles) off the Yorkshire coast in eastern England.
Besides the early endorsement by the Dogger Bank wind farm development consortium, consisting of SSE, Equinor and ENI, IWS’ investment programme and bespoke vessel design has found market approval through a raft of further contracts.
A three-year frame agreement, beginning in 2025, has been signed with Siemens Gamesa Renewable Energy, calling for the use of IWS Skywalker-class vessels to support offshore turbine commissioning works across multiple projects in Europe. Moreover, a timecharter contract has been secured from Greek undersea cable specialist Asso. subsea, which will entail deployment of a CSOV in French waters for up to eight months.
In the meantime, a charter deal with Dutch Governmentowned European transmission system company TenneT will
PRINCIPAL PARTICULARS - IWS Skywalker
Length overall 89.9m
Length bp 78.8m
Breadth 19.6m
Depth 7.5m
Draught 5.8m
Gross tonnage 6,709t
Deadweight 2,177t
Main generator engines 3 x Cat 3512E
Battery capacity 2.2MWh
Service speed 13kn
Class DNV
Class notations 1A Offshore Service Vessel (Windfarm Maintenance), E0, BIS, Strengthened (DK), COMF (V-2, C-2), NAUT-OSV, CLEAN (DESIGN), Recyclable, DYNPOS (AUTR), BWM-(T), Crane, Walk2Work, battery (power), LCS, ER (SCR), SILENT (E), CyberSecure, HELDK-SH
Accommodation 30 crew + 90 clients
Registry Norway (NIS)
IWS programme of CSOVs
NameDelivery
IWS SkywalkerDec 2023
IWS WindwalkerMar 2024
IWS Seawalker2Q 2024
IWS Starwalker3Q 2024
IWS Moonwalker2Q 2025
IWS Sunwalker3Q 2025
provide a minimum four months’ employment, starting at the end of May 2024, for the second ship of the series, IWS Windwalker. The vessel completed sea trials during December, and is scheduled to be delivered in March.
IWS said that the six CSOVs were ordered at an attractive, average fixed yard price of EUR48.2m ($52.2m) per vessel, which included specific equipment and features that would add about EUR5m ($5.4m) to standard yard prices. Significantly, the contract price has been based on use of about 50% Norwegian equipment and content. The favourable capex offers the prospect of improved yields in a rising market.
Norway’s Ministry of Climate and Environment agency ENOVA has granted EUR1m per vessel to support the environmental technology initiatives in the IWS Skywalker series. Projected energy consumption is estimated to be 20% lower than other newbuild CSOVs.

8 IWS Skywalker has been chartered by the Dogger Bank Wind Farm development consortium for service during the first two phases of construction (A and B)
For the latest news and analysis go to www.motorship.com MARCH/APRIL 2024 | 45


•Bilge
•Seals
•Dry
•Underwater
•Additives
•Marine
•Project
•Service



9
9
9
9
9
9
Tel: +49-2938-98769-0 info@chair-systems.com http://www.pilotchairs.com


Maintaining
●
● Support for all Viking based products and our new simple to install Viking352G upgrade pack (below)
●
●
●
●
●
●




Regulateurs Europa Limited Port Lane, Colchester. CO1 2NX UK
Phone +44 (0)1206 799556
Fax +44 (0)1206 792685Email sales@regulateurseuropa.comWeb www.regulateurseuropa.com

Torsional
Maintenance
Tel:










Formerly










46 | MARCH/APRIL 2024For the latest news and analysis go to www.motorship.com PRODUCTS & SERVICES DIRECTORY BRIDGE EQUIPMENT
NAUTIC PRO THE COMFORTABLE
High quality upholstery with individual logo stitch (optional)
Adjustable armrests
Variable seat depth
Infinitive height adjustment of the seat top
Seat angle adjustment
Length adjustment of the seat top FUELS & OILS DAMPERS CONTROL & MONITORING BEARINGS CONTROL & MONITORING EMISSION CONTROL
the highest possible standards for our customers. Service, upgrades and retrofits.
Governors / Actuators
Spare parts & Service
overhauls and service exchange units
OEM quality
Controls
Propulsion
Controls
Generator
Power Management
Turbocharger Condition Monitoring systems
atzmartec.com Experts in marine engineering equipment
water monitors & filtration
and bearings
dock services
repairs
to prevent leakage
engineering consultancy
management
contracts
Vibration Dampers
and Repair of Crankshaft
Viscous Vibration Dampers
Torsional
davidwhitaker@metaldyne.com www.metaldyne.co.uk
+44 (0)1422 395106 Fax: +44 (0)1422 354432
your damper providing engine protection? LUBRICANTS Explore our range of innovative, high performance and Environmentally Acceptable Lubricants, delivered with an unparalleled level of personal service. For more information please contact us at Vickers Oils 6 Clarence Rd, Leeds, LS10 1ND, UK Tel: +44 (0)113 386 7654 Fax: +44 (0)113 386 7676 Email: inbox@vickers-oil.com Web: www.vickers-oil.com TRUSTED FOR GENERATIONS MAINTENANCE PROPULSION AEGIR-MARINE, BUILT ON SERVICE Call us at +31 343 432 509 or send us an email: info@aegirmarine.com Reliable measurement, optimization and monitoring solutions for fuel oils. info@aquametro-oil-marine.com www.aquametro-oil-marine.com For more information visit: seawork.com contact: +44 1329 825335 or email: info@seawork.com 11 13 TO JUNE 2024 Southampton United Kingdom Seawork directory indd 1 25/07/2023 11:27
Simpson Ind - Holset Dampers Is


































For the latest news and analysis go to www.motorship.com MARCH/APRIL 2024 | 47 PRODUCTS & SERVICES DIRECTORY SPARE PARTS High quality underwater repairs Hydrex offers underwater repair solutions to shipowners around the globe. Our experienced teams are qualified to perform all class-approved repair procedures in even the harshest conditions. Hydrex headquarters Phone: +32 3 213 53 00 (24/7) E-mail:hydrex@hydrex.be www.hydrex.be Hermann-Blohm-Str. 1 · D-20457 Hamburg Phone +49 40 317710-0 · Fax +49 40 311598 E-mail info@nds-marine.com www.nds-marine.com Our reliability.Your move. Big enough to handle it Small enough to care Your Ship Repair Yard in Lisbon Estaleiro da Rocha Conde de Óbidos 1399 –036 Lisboa –PORTUGAL Tel. Yard (+ 351) 213 915 900 www.navalrocha.com navalrocha@navalrocha.pt TESTING & ANALYSIS SHIPREPAIR TEMP CONTROL TURBOCHARGERS WASTE WATER ENGINEERING CO. LTD. TEMPERATURE CONTROL VALVES Comprehensive range of 3-way Valves suitable for Fresh Water, Lubricating Oil and Sea Water Systems Wide choice of materials. Robust construction, low maintenance, simple to use and cost effective method of temperature control Tel: +44 (0) 1727 855616 Fax: +44 (0) 1727 841145 E-mail: Sales@waltonengineering.co.uk Website: www.waltonengineering.co.uk DIRECT • PNEUMATIC • ELECTRIC • GAS PRESSURE OPERATED VALVES Start Systems for Two and Four-Stroke Engines Please visit: www.seitz.ch LABORATORY ANALYSIS FOR THE MARINE INDUSTRY Tel: +44 (0) 1256 704000 Email:enquiries@spectro-oil.com Web: spectro-oil.com For more information contact us Phone: +44 141 880 6939 Email: mrhmarineoff@btconnect.com Or visit: www.mrhmarine.com Jets AS Vacuum Toilet Systems and STP’s, Jowa Water Handling Systems, Libraplast A60 Doors, Metizoft Green Passport Solutions, Modular Wet Units, Vacuum Pipe De-Scale Solutions and all kinds of bathroom and plumbing accessories you may require for any vessel 2950 SW 2nd Avenue Ft. Lauderdale, FL 33315 Toll free: 877-887-2687 Telephone: 954-767-8631 Fax: 954-767-8632 Email: info@turbo-usa.com www.turbo-usa.com Installing Turbocharger Confidence TURBOCHARGERS ABB Turbo MarineCare Predictability in a changing world Full range of CP Propulsion Systems • Reduction Gearboxes 150 • 12000 kW • PTO - PTI and 2 - Speed solutions • 3 - 4 and 5 bladed CP Propellers Ø1-6m dia
Fifth Generation Electronic Remote Controls • Nozzles NACA 19A Finnøy High Speed Finnøyveien 195 6487 Harøy NORWAY (+47) 712 76 000 post@finnoygear.no PUMPS PROPULSION
•
The Motorship’s first 50 years

The April 1970 issue of The Motorship marked 50 years since the magazine’s inception, and our predecessors began by noting that “it is difficult in any review of progress to isolate technical progress from nostalgia.”
“Fifty Years,” they continued, “is perhaps not a long time in the history of shipping, but it does cover the period of greatest marine engineering and shipbuilding developments.”
That certainly rings true today. It is not unreasonable to assume that the next 50 years will, out of necessity, prove somewhat more revolutionary than the last – maybe even more than the 1920-1970 period. With this in mind, it was fascinating to see how, in April 1970, one commentator viewed the development of marine fuels up to 2020.
The industry was aware of fuel cells in 1970, but felt there was no evidence they could be scaled up to marine energy demands. So oil was likely to continue to dominate the scene into the 21st century, ahead of gas turbines and, to a lesser extent, nuclear power. The oil industry was seen as having the capability and flexibility to meet all future fuel demands, at a low cost, and with a steady differential between residual and distillate fuel grades, with no chance of shortages of either type, thanks to ever-increasing world oil reserves. The increase in use of distillate fuels was correctly predicted, but this was mainly because the higher quality fuel would permit higher power outputs, and hence faster ships, while reducing ‘out of service’ time and enabling unmanned machinery rooms – emissions to air were not considered. The writers were aware that LNG had technical attractions, but fundamental storage and handling problems meant it was unlikely to be adopted on any significant scale. Unspecified ‘alternative energy sources’ did at least get a mention, but it was unlikely we would see any of these becoming viable until the first quarter of the 21st century – until then, petroleum products, albeit with ever-more refinement to enhance fuel quality and efficiency, would dominate.
As the April 1970 issue was devoted entirely to
looking back, there was no news of current vessels or technical developments. But the nostalgia did not concern only The Motorship’s main raison d'être, i.e. ship propulsion. One article pointed out that April 1970 was not just The Motorship’s 50th anniversary, but marked 70 years of marine radio. But it was not until 1916 that radio became mandatory, a necessity rather than a luxury. That move was prompted not only by the beginning of WW1 and the consequent dangers for commercial shipping, but by the Titanic, Volturno and Empress of England disasters in 1912-14.
Perhaps the most significant development in the marine diesel engine over those 50 years was the way that output power increased while size decreased. The output of the ‘super large bore’ engines of 50 years ago, at just under 4,000bhp per cylinder, is indeed modest in comparison with later developments, but the power-to-weight and power-to-size ratios were impressive when compared to engines from the 1920s. An article from the Dutch Werkspoor company was illustrated by a picture featuring three of the company’s engines, each rated at 3,000 bhp, showing how size and weight had reduced over just 20 years.

The international magazine for senior marine engineers
EDITORIAL & CONTENT
Editor: Nick Edstrom editor@mercatormedia.com
Correspondents
Please contact our correspondents at editor@motorship.com
Bill Thomson, David Tinsley, Wendy Laursen
SALES & MARKETING
Brand manager: Sue Stevens sstevens@mercatormedia.com
Tel: +44 1329 825335
Production
David Blake, Paul Dunnington production@mercatormedia.com
EXECUTIVE
Chief Executive: Andrew Webster awebster@mercatormedia.com
TMS magazine is published bi-monthly by Mercator Media Limited
Spinnaker House, Waterside Gardens, Fareham, Hampshire PO16 8SD, UK
t +44 1329 825335
f +44 1329 550192
info@mercatormedia.com www.mercatormedia.com
Subscriptions
Subscriptions@mercatormedia.com
Register and subscribe at www.motorship.com
1 year’s digital subscription with online access £236.00 For Memberships and Corporate/multi-user subscriptions: corporatesubs@mercatormedia.com

48 | MARCH/APRIL 2024For the latest news and analysis go to www.motorship.com 50 YEARS AGO
© Mercator Media Limited 2024. ISSN 0027-2000 (print) ISSN 2633-4488 (online). Established 1920. The Motorship is a trade mark of Mercator Media Ltd. All rights reserved. No part of this magazine can be reproduced without the written consent of Mercator Media Ltd. Registered in England Company Number 2427909. Registered office: Spinnaker House, Waterside Gardens, Fareham, Hampshire PO16 8SD, UK
8 Three Werkspoor engines, all rated at 3,000bhp, shown to scale, demonstrating the reduction in size and weight
8 A ship’s radio room (or ‘wireless cabin’) from 1920, equipped with direction finder, receiver, and spark-gap transmitter







MOTORSHIP MARINE TECHNOLOGY THE Contact us today Reach industry professionals with The Motorship Promote your business to the right audience in the right place at the right time. Engage with our audience of senior marine engineers, from ship owners and commercial partners a wide range of opportunities for campaign delivery. We Motor Ship’s valued content is relied upon by shipping professionals and is delivered through multiple channels. Sue Stevens, Brand Manager t: (+44) 1329 825 335 e: sales@motorship.com www.motorship.com MAGAZINE RECIPIENTS DECISION MAKERS PAGEVIEWS PER MONTH 13,00072%31,000

Hamburg Germany

Providing










Propulsion & Future Fuels is the longest-running technical conference in the maritime sector, providing senior executives with a meeting place to learn, discuss, and share knowledge
Visit: motorship.com/propulsion-and-future-fuels-conference
Contact: +44 1329 825335
Email: conferences@propulsionconference.com






45TH 21 TO NOV 19
#MotorshipPFF
on methanol
new projects
performance
new engines, pollution control, fuel tanks) and 4-stroke engines additive packages into the maritime market will mean and
engine
discuss and share knowledge of Topics & Presentations cover: Join us in November
Riverside Hotel MOTORSHIP MARINE TECHNOLOGY THE Media partner: Media supporters: Supported by:
by:
senior executives with a meeting place to learn,
Empire
Sponsored













 8 Dan Cronin, VP Class Standards & Software at ABS
8 Dan Cronin, VP Class Standards & Software at ABS